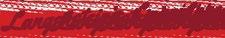

MARDI GRAS MANUAL

IT’S ALWAYS “CARNIVAL TIME” WITH AL JOHNSON p. 8


WhereYat.com February 202 3 DINING • MUSIC • ENTERTAINMENT • NIGHTLIFE










SUNDAY BRUNCH HAPPY HOUR NOON - 4P CHICKEN AND BACON PECAN WAFFLES CAJUN CUT BEEF TENDERLOIN BENEDICT & MORE! $4 SPECIALTY DRINKS 1/2 PRICE APPETIZERS 20% OFF COUPON FOR YOUR NEXT VISIT FOR FIRST TIME GUESTS HOUSE CHAMPAGNE PACKAGE | $24 UPGRADED CHAMPAGNE PACKAGE WITH KORBEL | $44 THURSDAY - SATURDAY 5P – 7P THURSDAY - SATURDAY | 5P - 9:30P SUNDAY BRUNCH | NOON - 4P Must be 21 years of age or older. Management reserves the right to change, cancel or modify this program at any time with applicable Gaming Regulation. Offer not valid for self-exclusion program enrollees in jurisdictions which Penn National Gaming, Inc. operates or who have been otherwise excluded from the participating property. ©2021 Penn National Gaming, Inc. All rights reserved. GAMBLING PROBLEM? CALL 800.522.4700 BoomtownNewOrleans.com • 504.366.7711 Must be 21 years of age or older. Management reserves the right to change, cancel or modify this program at any time with applicable Gaming Regulation. Offer not valid for self-exclusion program enrollees in jurisdictions which PENN Entertainment, Inc. operates or who have been otherwise excluded from the participating property. ©2023 PENN Entertainment, Inc. All rights reserved.


WhereYat.com | February 2023 3





















Use code WHEREYAT for SPECIAL SAVINGS! AND MORE!
Anders
Mike
Chef
Dirty
Brass Band John
John “Papa” Gros
Jon Cleary & The Absolute Monster Gentlemen Rockin’ Dopsie Jr. & The Zydeco Twisters Frenchy
The Meters
Little Feat
Osborne Jimmy Hall Irma Thomas
Zito Cha Wa
Kevin Belton
Dozen
Boutté
Tab Benoit
Leo Nocentelli from
Johnny Sansone
SAMANTHA FISH
Island Swamp Band *Cruise guests will be treated, at no additional cost, to an exclusive Galactic performance at famed club Tipitina’s while the Big Easy Cruise visits New Orleans SPECIAL APPEARANCE BY GALACTIC* featuring Anjelika “Jelly” Joseph Ft. Lauderdale A New Orleans A Cozumel NOVEMBER 4-11, 2023 ABOARD Holland America Line NieuwAmsterdam Let the good times roll on the big easy cruise! BigEasyCruise.com/WHEREYAT A (855) 923-7456 Artists and ports subject to change BigEasyCruise
Tuba Skinny Honey


Oh, it’s Carnival time! Enjoy our 104-page, largest-issue ever as Where Y’at enters our 25th year of publishing. This issue has all the intel about Mardi Gras, including parade maps, king cake picks, and more.
Emily Hingle visits with the man, the myth, the legend: Al “Carnival Time” Johnson. Mr. Johnson recalls stories like when he recorded “It’s Carnival Time” 63 years ago, just before performing for President John F. Kennedy.
Cythea Corfah shares the most coveted throws for this Carnival season, highlighting everything from Zulu coconuts to Tucks plungers. Frances Deese shares tips on how to make your own costume for Mardi Gras day.
Not to be forgotten in the Carnival madness, Julie Mitchell asks “Are You in Love?” in her hilarious piece on Valentine’s Day. And Jeff Boudreaux shares his picks for movies to watch to celebrate Black History Month.


Be sure to log onto WhereYat.com for up-to-date info… happy Carnival.
YEARS
February 2023
Publisher/Editor-in-Chief: Josh Danzig
Creative Director: Robert Witkowski
Executive Editor: Reine Dugas
Copy Editor: Donald Rickert
Movie Editors: David Vicari, Fritz Esker
Contributing Writers: Kathy Bradshaw, Phil LaMancusa, Debbie Lindsey, Kim Ranjbar, Burke Bischoff, Julie Mitchell, Greg Roques, Sabrina Stone, Kimmie Tubre, Emily Hingle, Camille Barnett, Celeste Turner, Cynthea Corfah, Kevin Credo, Frances Deese
Cover Photo: Al "Carnival Time" Johnson in Krewe of Tucks Den by Romney Caruso


Director of Sales: Jim Sylve

Photographers and Designers: Gus Escanelle, Kim Ranjbar, Emily Hingle, Kathy Bradshaw, Robert Witkowski
Interns: Jared Eaglin, Mia Oliva, Louis Ostrowski, Mercedes Ohlen, Arielle Gonzales
Subscribe: Receive 1 year (14 issues) for $30 and get a FREE Where Y’at phone credit card holder. Subscribe today at WhereYat.com.
Logo ©2023 All rights reserved
Bruce Betzer, Legal Counsel: (504) 304-9952

Where Y’at Magazine 5500 Prytania St., #133 New Orleans, LA 70115 (504) 891-0144


info@whereyat.com
WhereYat.com
6 Mardi Gras Manual | Where Y'at Magazine 30
–Josh Danzig, Publisher Extras Entertainment & Nightlife 48 Live Music Calendar 58 Lakeside2Riverside 94 Movie Reviews 100 Where Y'Been 64 Fat Tuesday Pancakes 66 King Cakes Slices to Die For 70 Let Them Eat King Cake 74 $20 & Under 80 Dining Guide 88 Bar Guide 14 Mardi Gras Parade Maps 24 Mardi Gras Marching Groups 26 Northshore Mardi Gras Parades 28 Mardi Gras Parade Calender 96 Tales From the Quarter 98 Po-Boy Views 8 Al "Carnival Time" Johnson Busts a Move 30 Most Coveted Throws 34 History of Gay Mardi Gras 36 Carnival Costume Culture 42 Mardi Gras Secrets 46 Carnival's Rainbow 62 Valentine's Day Quiz 90 Black History Month Movies Features Food & Drink 66 24
Letter from the Publisher CONTENTS CLOCKWISE, FROM TOP: ADOBE STOCK; ROBERT WITKOWSKI; WILLA JEAN; JARED EAGLIN; GUSTAVO ESCANELLE
NEW!



“IT’S
CARNIVAL TIME”
Declares Al Johnson
You’ve heard it a hundred times or more. The song
“Carnival Time” is the epitome of music made to celebrate Mardi Gras in New Orleans. Just the opening bars are enough to get people up and dancing, filled with joy for the season and anticipation of Fat Tuesday. Though the beloved song was released back in 1960, it shines like a beacon welcoming in Mardi Gras revelers from around the world into the streets for a party.

 ROMNEY CARUSO
By Emily Hingle
ROMNEY CARUSO
By Emily Hingle
8 Mardi Gras Manual | Where Y'at Magazine
Portrait Photography By Romney Caruso




















































































































































WhereYat.com | February 2023
“Coming up, we used to say carnival instead of Mardi Gras. Carnival is the season and Mardi Gras is just a day. And I said that it was time to do something for carnival. So I came up with ‘Carnival Time,’" explained the song’s writer and performer Al Johnson. “I noticed that every year, it sounds like it’s brand new. Everybody knows all the words to it, and everybody seems happy with it, and that makes me happy.”
Indeed, New Orleanians and visitors to the city alike love “Carnival Time” and have for 63 years. It’s often used as a tune for the many marching clubs that come out during parades because the song is so recognizable. Michael Anding, Vice President of the Lyons Club, said

“'Carnival Time’ means the nearing of gatherings and jubilant parties, costumes and music, revelry in the streets and king cake in the belly." Dames de Perlage member Lesli Richard stated, “It makes me think of pure revelry: dancing, singing, and drinking in the streets. The feast before the fast, drinking wine any time of day or night, having people you don’t know join you in dance and song because we all understand that’s what Carnival is about.”


“Carnival Time” may be the bestknown New Orleans Carnival season song, but Al Johnson had no way of knowing the impact that his song would have when he went into the studio to record all those years ago.


Al was a young boy when his father gave him a trumpet in the hopes that he would become a “small Louis Armstrong” one day. He remembered, “Daddy bought me a trumpet, and he bought my sisters a piano, and he bought one of my

10 Mardi Gras Manual | Where Y'at Magazine
FROM TOP: WIKIPEDIA COMMONS / MARK "SWAG" ROSENZWEIG; GUSTAVO ESCANELLE; COURTESY AL"CARNIVAL TIME" JOHNSON
Where Italy meets the South. The unlikely marriage between classic Italian recipes and the bright and mystifying flavors of the American South.

STICK TO THE SCRIPT. DRINK RESPONSIBLY. KAHLÚA® Rum and Co ee Liqueur. 20% Alc./Vol. (21.5% alc./vol., available only in Ohio). Product of Mexico. ©2021 Imported By The Kahlúa Company, New York, NY. aNd KiNg CaKe! THE PERFECT PAIRING THIS CARNIVAL SEASON a N d KiNg CaKe! EsPrEsSo MaRtInI 1pt Kahlua 1pt Absolut Vodka 1pt Espresso EsPrEsSo MaRtInI
brothers a trombone and another one a saxophone. He was a music lover, and I guess he tried to instill us with music at a young age. I guess I was about 8 or 9. He liked Satchmo, Fats Waller… He liked the true jazz music. But that didn’t work out like that.”


While Al did take lessons on the trumpet, his heart belonged to the piano. He wanted to be less like Louis Armstrong and more like his favorite musician—Fats Domino. He got into writing songs in a matter of minutes and recorded them at local studios starting when he was 17. In 1960, Al wrote “Carnival Time” in just “10 or 15 minutes,” then he brought it to legendary recording engineer Cosimo Matassa’s studio to record it. Al said, “Cosimo had a way of making music sound good. He did a good job for music in New Orleans.”



There was only one problem during this historic recording session. Al continued, “I had trouble because they told me that the way to make a hit is to make something different. I was trying to do that, and they were giving me a hard time.” Specifically, the studio musicians hated the line “Right now!” which comes just after the chorus. “They said that the part that I added in there where I sing ‘Right now!’ was off of the timing and
shouldn’t put that in there. The studio had some session musicians from Fats Domino’s band, Guitar Slim, Smiley Lewis, Ernie K. Doe. They thought it was so terrible. I thought it should be in there. We battled for a couple of years over it. Eventually they agreed, and we put that in there. A lot of people thought that was fantastic. They said that you have to be different, and I was trying to be different.”

Just after recording “Carnival Time” in 1960, Al Johnson went into the military and was stationed at Fort Bliss, Texas. His musical career didn’t end there, however. “I played well enough to get into the army band. We played mostly marches, and we had a studio band that played other arrangements. I was doing a little Fats Domino music on the side on the base. We traveled some outside of the base some where they wanted the army band to play. We played for President Kennedy a couple of weeks before [he died]. I remember that well,” Al said. While Al never had a full-time career as a musician, he has remained on-hand to play his famous song and other tunes around town as a featured artist. His dedication to making people dance to “Carnival Time” has earned him a spot in the Louisiana Music Hall of Fame and the distinction of being called the Grand Marshal of Krewe of Red Beans for life. Al was also chosen to perform for President Barack Obama when he was in office.
Al looked around his Musicians’ Village home filled with memorabilia, memories, and lots of Mardi Gras accessories. He was especially proud of his photo with his “idol” Fats Domino and Little Richard. He said with a smile, “Music has been great. I played an important part to say that it helped New Orleans to be what it is. I’m glad to be a part of that. There’s only one Mardi Gras day, but the rest of those days are carnival time. I’m saying it’s carnival time all the time!”

12 Mardi Gras Manual | Where Y'at Magazine
THE PERFECT VALENTINE’S DATE SPOT! BOOK NOW! 1200 Poydras St. Suite 103 | 504- 577-2937 | stumpyshh.com/neworleansla BEFORE OR AFTER Join Us the Parades 544 Carondelet St barmarilou.com @barmarilou A spirited sanctuary in the heart of New Orleans. You’re invited. COLUMBIA/LEGACY/ RIC RECORDS














WhereYat.com | February 2023 13 LIMITED TIME OFFER ©2023 Califon Productions, Inc. All Rights Reserved. JOIN THE CLUB AND SHARE YOUR EMAIL, GET $25 IN FREE PLAY! PLUS, ALL POINTS EARNED ON OUR NEW GAMES CAN NOW BE REDEEMED FOR FREE PLAY! VISIT ANY PARTICIPATING FAIR GROUNDS OTB & CASINO LOCATION TO GET STARTED: BOUTTE, CHALMETTE, DESTREHAN, HOUMA, KENNER, MERAUX, METAIRIE & WESTWEGO Must be 21 years of age and have valid government-issued photo ID. Fair Grounds OTB & Casinos Rewards Club Card may only be used for HRM games; not valid on Video Poker. Join the Club Offer valid at select OTB & Casino locations only. FAIR GROUNDS OTB & CASINOS JUST GOT MORE REWARDING! FGNO-45344-NewMember_RedeemPoints-WhereYat-2.4-Ad_4.78x10.75.indd 1 1/25/23 2:57 PM 6 HISTORIC BLOCKS OF SHOPPING, DINING & EVENTS • OPEN DAILY • Featuring clothing, jewelry, arts and crafts, home decor, children’s toys, unique gifts and souvenirs St. Ann St. Dumaine St. N. Peters St. PARKING PARKING RIVERSIDE STREETCAR LINE THE FRENCH QUARTER Decatur St. Decatur St. Barracks St. Esplanade Ave. Chartres St. St. Peter St. St. Phillip St. Ursulines Ave. CARNIVAL TIME • IN THE • LEARN MORE AT FRENCHMARKET.ORG FrenchMktNOLA French Market New Orleans
Mardi Gras Parade




14 Mardi Gras Manual | Where Y'at Magazine
LOUISIANA AVE. . PONTCHARTRAINEXPRESSWAY. . NAPOLEON AVE . . MAGAZINE ST. . LASALLEST. . POYDRAS ST. . JULIA ST. . MARTINLUTHERKING,JR.BLVD.. ST.CHARLESAVE. . ST. CHARLES AVE. . LOYOLA AVE. . CANALST. . UNION TRAIN STATION RIVER WALK OUTLETSMISSISSIPPI RIVER VETERANS BLVD. . INTERSTATE 10 W. ESPLANADE AVE. . VETERANS BLVD. . N. CAUSEWAY BLVD. CALEARY AVE. . BONNABEL BLVD. SEVERN AVE. CLEARVIEW PKWY. LAKE PONTCHARTRAIN French Quarter N. RAMPART ST. CHARTRES ST. BOURBON ST. ROYAL ST. . ST. ANN ST. ST. PETER ST. . JACKSON SQUARE Parade schedules and routes are subject to change. Check whereyat.com for updates. JEFFERSON AVE. . ST.CHARLESAVE.. TCHOUPITOULAS ST. . Uptown Metairie GUSTAVO ESCANELLE "Throw
me somethin', Mista'!"
2023
Maps
Cork
Fri., February 10, 3:00 p.m.
With its wine-themed costumes and beads with a grape logo, this parade proudly celebrates wine and fun.
Oshun
Fri., February 10, 6:00 p.m.
This parade features Barry Barth floats, as well as a peacock float that carries the krewe’s captain.
Cleopatra
Fri., February 10, 6:30 p.m., Follows Oshun
Founded in 1972, this all-female krewe is now over 50 years old and has around 1,800 members.
Excalibur (Metairie)
Fri., February 10, 6:30 p.m.
This parade is led by knights on horseback and has a number of fully animated floats.
Symphony (Metairie)
Fri., February 10, 7:00 p.m., Follows Excalibur
This all-male krewe originally started with a ball in 2008 and didn’t have its first parade until 2020.

ALLA
Fri., February 10, 7:00 p.m., Follows Cleopatra
Non-marching dogs are welcome to enjoy from the sidelines.
Legion of Mars
Sat., February 11, 11:30 a.m.
Founded by combat veterans in 2013, the krewe honors veterans and those currently serving in the United States military.
Pontchartrain
Sat., February 11, 1:00 p.m..
The parade has some of Carnival’s most memorable floats including “The Super Grouper” and “The Mudbug."
Choctaw
Sat., February 11, 2:00 p.m.,
Follows Pontchartrain

This formerly Westbank parade now rolls Uptown and is known for its hand-decorated tomahawks.
Freret
Sat., February 11, 3:00 p.m., Follows Choctaw
This co-ed krewe, which has been around for over 50 years, and is very popular because of its locally produced and decorated throws.
MadHatters (Metairie)

Sat., February 11, 5:00 p.m.
This krewe brings the madness and fun of Alice in Wonderland to life every Mardi Gras.

Knights of Sparta
Sat., February 11, 5:30 p.m.
Named after the famous ancient Greek city-state, this all-male krewe is known for its elaborate bal masque and traditional street parade.
WhereYat.com | February 2023 15
ROBERT WITKOWSKI
Balcony seating
2023
Mardi Gras Parade Maps


Pygmalion
Sat., February 11, 6:15 p.m., Follows Knights of Sparta Founded in 2000, this parade has an incredibly fun after-party called Pygmalionfest.
Femme Fatale
Sun., February 12, 11:00 a.m. This all-woman krewe has signature bejeweled compact mirror throws.
Carrollton
Sun., February 12, 12:00 p.m., Follows Femme Fatale
This krewe is the fourth oldest Carnival parading organization and is known for its sustainability and innovation.
King Arthur
Sun., February 12, 1:00 p.m., Follows Carrollton
Originally founded on the Westbank in 1977, this parade is one of the largest parades in the entire Carnival season.
French Quarter
Druids
Wed., February 15, 6:15 p.m.
This group, whose members belong to other Carnival groups, is named after the priests in Ancient Celtic societies.
Nyx
Wed., February 15, 6:45 p.m., Follows Druids
Past “goddesses” of this krewe have included well known locals including Irma Thomas, Susan Spicer, and the Dixie Cups.
Babylon
Thu., February 16, 5:30 p.m. Founded in 1939 by The Jester’s Club, this krewe uses floats that incorporate styles used more than 70 years ago.
Chaos
Thu., February 16, 6:00 p.m., Babylon Chaos lives up to its name with skewering satire.
Muses (+ )
Thu., February 16, 6:45 p.m., Follows Chaos
In addition to its very popular parade and throws, this krewe is known best for its year-long philanthropic efforts.


16 Mardi Gras Manual | Where Y'at Magazine
LOUISIANA AVE. . JACKSON AVE. PONTCHARTRAINEXPRESSWAY. . NAPOLEON AVE . . MAGAZINE ST. MAGAZINEST. . POYDRAS ST. JULIA ST. . MARTINLUTHERKING,JR.BLVD.. ST.CHARLESAVE.. ST. CHARLES AVE. . LOYOLA AVE. . LAFAYETTE CEMETERY NO. 1 CANALST. . UNION TRAIN STATION RIVER WALK OUTLETSMISSISSIPPI RIVER N. RAMPART ST. BURGUNDY ST. DAUPHINE ST. ST. ANN ST. ST. PETER ST. . JACKSON SQUARE
Parade schedules and routes are subject to change. Check WhereYat. com for updates. FROM TOP: GUSTAVO ESCANELLE; ROBERT WITKOWSKI (2)
Uptown
Muses Parade
Mardi Gras parades are more fun with friends



























































WhereYat.com | February 2023 17 Metairie Carnival 2023 For more information contact the Jefferson Convention & Visitors Bureau, Inc. 504-731-7083 | www.visitjeffersonparish.com Battle for bragging rights and prize money! 1st Place 2nd Place 3rd Place $3,000 $2,000 $1,000 awarding winners at every metairie parade: Watch Middle and High School Bands COMPETE with their BEAT along Veterans Boulevard, Metairie! Root for your school marching band!
Mardi Gras Parade Maps





Algiers French Quarter
NOMTOC (Algiers)
Sat., February 18, 10:45 a.m.
This parade first rolled on the Westbank in 1970 and remains one of the only parades still left on the Westbank.
Iris
Sat., February 18, 11:00 a.m.
First organized in 1917, Iris is the longest running female Carnival krewes in New Orleans.
Tucks
Sat., February 18, 12:00 p.m.
Bosom Buddies
Fri., February 17, 11:30 a.m.
Reflecting its name, this krewe’s most signature throws are its hand-decorated bras.
Hermes
Fri., February 17, 5:30 p.m.
The inaugural parade was in 1938, and Hermes was one of the first to reorganize after Hurricane Katrina.
Krewe d'Etat
Fri., February 17, 6:30 p.m., Follows Hermes
The krewe's theme is made known to the public on parade day.
Morpheus
Fri., February 17, 7:00 p.m., Follows Krewe d’Etat
This inclusive, co-ed krewe incorporates more than 800 female and male riders.
Founded by Loyola students in 1969, this parade’s most famous float is the King’s Throne toilet float.

Endymion
Sat., February 18, 4:00 p.m.
One of Carnival’s super-krewes, Endymion incorporates over 3,000 riders for its parade.

Isis (Kenner)
Sat., February 18, 6:00 p.m.
This all-female krewe, which will roll in Kenner, is celebrating its 50th anniversary this year.

18 Mardi Gras Manual | Where Y'at Magazine 2023
LOUISIANA AVE. . INTERSTATE10 INTERSTATE10. PONTCHARTRAINEXPY. . POYDRASST. MARTINLUTHERKING,JR.BLVD. FAIR GROUNDS RACE TRACK CANALST. . ORLEANSST. . N.GALVEZST.. N.BROADST. S.BROADST.. S.BROADST. . CARROLLTONAVE. NORMANC.FRANCISPKY.. CITY PARK AVE . . ESPLANADEST. . CAESAR'S SUPERDOME LEE CIRCLE Mid-City W. ESPLANADE AVE. VINTAGE DR. . JOY YENNI BLVD. LOYOLA DR. W. LOYOLA DR. . WILLIAMS BLVD. CHATEAU BLVD. . Kenner MARDI GRAS BLVD. OPELOUSAS ST. L B LANDRY ST. GENERALMEYERAVE. L B LANDRY ST. NEWTON ST. MISS. RIVER ROYAL ST. BOURBON ST. CANAL ST. ST. ANN ST. ST. LOUIS ST. IBERVILLE ST. CONTI ST. JACKSON SQUARE CHARTRES ST. LOUISIANA AVE. . JACKSON AVE. . PONTCHARTRAINEXPY. NAPOLEON AVE . MAGAZINE ST. . MAGAZINEST. LASALLEST. POYDRAS ST. . JULIA ST. . MARTINLUTHERKING,JR.BLVD.. ST.CHARLESAVE. . ST. CHARLES AVE. . LOYOLA AVE. . LAFAYETTE CEMETERY NO. 1 UNION TRAIN STATION MISSISSIPPI RIVER
Tucks parade
FROM TOP: GUSTAVO ESCANELLE; ROBERT WITKOWSKI (2)
Endymion parade
Uptown

WhereYat.com | February 2023 19
Mardi Gras Parade Maps


Okeanos
Sun., February 19, 11:00 a.m.
Originally founded as a St. Claude parade in 1949, Okeanos now rolls down a large section of St. Charles Avenue.
Mid-City
Sun., February 19, 11:45 a.m., Follows Okeanos
Known for its themes dedicated to children, Mid-City was the first krewe to use animated floats in the ‘40s.
Thoth
Sun., February 19, 12:00 p.m.
Now in its 75th year, Thoth dedicates itself to bringing Mardi Gras to people who are unable to visit other parades in NOLA.
Bacchus
Sun., February 19, 5:15 p.m.
One of Carnival’s most popular parades, Bacchus is known best for its many super-floats and national celebrity kings.

Athena (Metairie)
Sun., February 19, 5:00 p.m., Follows Athena
This all-female krewe was founded in 2014 by Mardi Gras veterans to promote sisterhood and service.
Atlas (Metairie)
Sun,. February 19, 5:30 p.m. Reflecting its belief in equality for all, this krewe is made up of people from all walks of life.
Proteus
Mon., February 20, 5:15 p.m.
Proteus is the second-oldest krewe in New Orleans Carnival and still uses its original 1800s float chassis.

Orpheus
Mon., February 20, 6:00 p.m.,
Follows Proteus
This 700+ super krewe was founded by musician Harry Connick, Jr. and his father.
Centurion (Metairie)
Sat., February 20, 6:30 p.m. In addition to its parade, this co-ed krewe organizes family-oriented activities throughout the year.
20 Mardi Gras Manual | Where Y'at Magazine
FROM LEFT: ROBERT WITKOWSKI; KREWE OF BACCHUS
2023
LOUISIANA AVE. . JACKSON AVE. PONTCHARTRAINEXPRESSWAY. . NAPOLEON AVE . HENRY CLAY AVE. . JEFFERSON AVE. . MAGAZINE ST. . MAGAZINEST. . MAGAZINE ST. LASALLEST. . POYDRAS ST. . JULIA ST. . MARTINLUTHERKING,JR.BLVD.. ST.CHARLESAVE. . . ST. CHARLES AVE. . LOYOLA AVE. . LAFAYETTE CEMETERY NO. 1 CHILDREN'S HOSPITAL CANALST. . UNION TRAIN STATION RIVER WALK OUTLETSMISSISSIPPI RIVER Metairie VETERANS BLVD. . VETERANS BLVD. . N. CAUSEWAY BLVD. . SEVERN . CLEARVIEW PKWY. BONNABEL .
are
to change. Check WhereYat.com for updates. Orpheus
Parade schedules and routes
subject
parade
Bacchus Uptown

















(504) 831-8637 • 2347 Metairie Road ENJOY OUR NEW PATIO HAPPY HOUR DAILY UNTIL 7PM Thank you to the readers for voting us ONE OF THE BEST BARS IN METAIRIE! PUB TRIVIA ON WEDNESDAY NIGHTS!
Mardi Gras Parade Maps



Zulu
Tue., February 21, 8:00 a.m. First appearing in 1909, Zulu’s handdecorated coconuts are some of the most prized throws in all of Carnival.
Rex
Tue., February 21, 10:00 a.m. The King of Carnival, Rex was formed in the 1800s to put on a spectacle for Russian Grand Duke Alexei Alexandrovich.
Elks-Orleans
Tue., February 21, 10:30 a.m., Follows Rex
This krewe is known best for its truck floats, which can carry over 4,000 riders.

Crescent City
Tue., February 21, 11:00 a.m., Follows Elks-Orleans
The second-oldest truck parade, Crescent City’s trucks represent different Carnival organizations.
Argus
Tue., February 21, 12:00 p.m.
Past empresses in this family-friendly krewe have included Shirley Jones and Phyllis Diller.
Elks Jefferson
Tue., February 21, 12:30 p.m., Follows Argus
Elks Jefferson is Jefferson Parish’s largest and oldest truck krewe with around 4,000 members.
Jefferson
Tue., February 21, 1:00 p.m., Follows Elks Jefferson
This krewe was formed in 1972 by former captains of the Krewe of Jason and Krewe of Elks Orleanians.
22 Mardi Gras Manual | Where Y'at Magazine
BONNABEL BLVD. VETERANS BLVD. . INTERSTATE 10 . W. ESPLANADE AVE. . VETERANS BLVD. . N. CAUSEWAY BLVD. SEVERN AVE. . CLEARVIEW PKWY. . LOUISIANA AVE. . TOLEDANO ST.D JACKSON AVE. . NAPOLEON AVE . . MAGAZINE ST. . MAGAZINEST. . JULIA ST. . MARTINLUTHERKING,JR.BLVD.. ST.CHARLESAVE. . LOYOLA AVE. . UNION TRAIN STATION CANALST. . S.CLAIBORNEAVE. . N.BROADST.. INTERSTATE10. PONTCHARTRAINEXPRESSWAY. CAESAR'SPOYDRASST.. SUPERDOME LAFAYETTE CEMETERY NO. 1 ORLEANSST. . Parade schedules and routes are subject to change. Check WhereYat.com for updates.
Uptown Metairie
2023
ALL PHOTOS: GWHERE Y'AT STAFF / KREWES
Zulu parade
Rex parade

Marching Group Parade Schedule
610 STOMPERS
Facebook
Poseidon Saturday, February 4
Raising Canes Block Party Saturday, February 11
Carrollton Sunday, February 12
Babylon Thursday, February 16
Iris Saturday, February 18
Thoth Sunday, February 19
689 SWAMPERS
Facebook
Alla Friday, February 10
Choctaw Saturday, February 11
Carrollton Sunday, February 12
Morpheus Friday, February 17
Rosethorne Saturday, February 18
AMELIA EARHAWTS & CABIN KREWE
aecabinkrewe.com and Facebook
Cleopatra Friday, February 10
King Arthur Sunday, February 12
Druids Wednesday, February 15
Babylon Thursday, February 16
Iris Saturday, February 18
BEARDED OYSTERS
beardedoysters.org and Facebook
Mad Hatters Saturday, February 11
Muses Thursday, February 16
BEYJORETTES
thebeyjorettes.com and Facebook
Nefertiti Sunday, January 29
Sparta Saturday, February 11
Zulu Tuesday, February 21
BOMBSHELLS
Facebook
Alla Friday, February 10
Excalibur Friday, February 10
Choctaw Saturday, February 11
Pygmalion Saturday, February 11
Carrollton Sunday, February 12
Druids Wednesday, February 15
Iris Saturday, February 18
Okeanos Sunday, February 19
Zulu Tuesday, February 21
BOSOM BUDDIES
Bourbon Street Friday, Februrary 17
CHAIRY CHICKS
Facebook
Mardi Paws Sunday, February 26
CRESCENT CITY FAE
Facebook
Freret Saturday, February 11
Druids Wednesday, February 15
Tucks Saturday, February 18
DISCO AMIGOS
discoamigosnola.com and Facebook
Poseidon Saturday, Februrary 4
Cleopatra Friday, February 10
King Arthur Sunday, February 12
Druids
2023
OUI DATS
Facebook
Poseidon Saturday, February 4
Cleopatra Friday, February 10
Sparta Saturday, February 11
Morpheus Friday, February 17
Mardi Paws Sunday, February 26
PUSSYFOOTERS
pussyfooters.org and Facebook
Cleopatra Friday, February 10
Nemesis Saturday, February 11
Carrollton Sunday, February 12
Muses Thursday, February 16
Thoth Sunday, February 19
KREWE DE MAYAHUEL
Facebook
Delusion
Sunday, February 5
Red Beans Monday, February 20
KREWE DES FLEURS
krewedesfleurs.org and Facebook
Cleopatra Friday, February 10
Iris Saturday, February 18
Orpheus Monday, February 20
MAHOGANY BLUE BABY DOLLS
Facebook Delusion
MANDE MILKSHAKERS
Sunday, February 5
mandemilkshakers.com and Facebook
Kings Day Parade Sunday, January 22

Posiedon
Sunday, February 12
Eve Saturday, February 18
Olympia Sunday, February 19
Carrollton
Selene
Tucks
Monday, February 20
Saturday, February 25
Sunday, February 26
Hera Tuesday, February 28
Covington
Wednesday, March 1
Argus Wednesday, March 1
Krewe Du Pooch
MUFF-A-LOTTAS
Sunday, March 5
muffalottas.com and Facebook
Cleopatra Friday, February 10
Pontchartrain Saturday, February 11
Babylon Thursday, February 16
Tucks
MYSTIC VIXENS
Saturday, February 18
mysticvixens.com and Facebook
Pearl River Sunday, Febrary 5
Mad Hatters Saturday, February 11

Selene Friday, Febrary 17
Spanish Town Saturday, February 18
Covington Tuesday, February 21
Mardi Paws Sunday, February 26
NOLA CHORUS GIRLS
Facebook
Freret Saturday, February 11
NOLA NIGHT LIGHTS
Facebook
Wedneday, February 15
Iris Saturday, February 18
Chewbacchus Saturday, January 28
Selene Friday, February 17
ROLLING ELVI Facebook
Cleopatra Friday, February 10
King Arthur Sunday, February 12
Muses Thursday, February 16
Iris Saturday, February 18
ROUX LA LA Facebook
Sparta Saturday, February 11
King Arthur Sunday, February 12
Morpheus Friday, February 17
SIRENS OF NEW ORLEANS
Facebook
Cleopatra Friday, February 10
Morpheus Friday, Feburary 17
SKINZ N BONEZ
Facebook
Bohème Friday, February 3
Muses Thursday, February 16
STAR-STEPPIN’ COSMONAUGHTIES
Facebook
Bohème Friday, February 3
Pygmalion Saturday, February 11
STREETCAR STRUTTERS
st.carstrutters.com and Facebook
Alla Friday, February 10
Barkus Sunday, February 12
Tucks Saturday, February 18
TRASHFORMERS
Facebook
krewedelusion Sunday, February 5
Parade
subject to
for updates. 24 Mardi Gras Manual | Where Y'at Magazine
schedules and routes are
change. Check WhereYat.com
ALL PHOTOS: WHERE Y'AT STAFF
Rolling Elvi
Pussyfooters
ARE WELCOME! Y’ALL
With fun and festivities for the whole family, come experience a bright and colorful Carnival season unlike any other in Baton Rouge! For the latest routes, roll times and more, check out visitbatonrouge.com/mardigras

Northshore Parade Schedule
Krewe of Titans (Slidell)
Friday, February 3 | 6:30 p.m.
Krewe of Bilge (Slidell)
Saturday, February 4 | 12:00 p.m.
Krewe of Poseidon (Slidell)
Saturday, February 4 | 6:00 p.m.
Krewe of Pearl River
Lions Club (Pearl River)
Sunday, February 5 | 1:00 p.m.
Krewe of Eve (Mandeville)

Friday, February 10 | 7:00 a.m.
Krewe de Paws of Olde Towne (Slidell)
Saturday, February 11 | 10:00 a.m.
Krewe of Push Mow (Abita Springs)
Saturday, February 11 | 12:00 p.m.
Krewe of Tchefuncte (Madisonville)
Saturday, February 11 | 1:00 p.m.
Krewe of Olympia (Covington)
Saturday, February 19 | 6:00 p.m.
Krewe of Titans (Slidell)
Saturday, February 11 | 6:30 p.m.
Krewe of Dionysus (Slidell)
Sunday, February 12 | 1:00 p.m.
Krewe of Selene (Slidell)
Friday, February 17 | 6:30 p.m.

Covington Lions Club (Covington)
Tuesday, February 21 | 10:00 a.m.
Krewe of Covington (Covington)
Tuesday, February 21 | Follows Lions
Krewe of Chahta (Lacombe)
Tuesday, February 21 | 1 p.m.
Krewe Du Pooch (Covington)
Saturday, February 25 | 12 p.m.
Krewe of Mardi Paws (Covington)
Sunday, February 26 | 2 p.m.
26 Mardi Gras Manual | Where Y'at Magazine
2023
Parade schedules and routes are subject to change. Check WhereYat.com for updates.

























WhereYat.com | February 2023 27 THE THRILLS. THE FUN. THE TRADITION. Purchase Tickets, Clubhouse Admission and Boxes on to save money and skip the long line on race days! WIENER DOG RACES SATURDAY, MARCH 11 • POST TIME: 1:15PM LOUISIANA DERBY PREVIEW DAY SATURDAY, FEBRUARY 18 • POST TIME: 12PM FGNO-45343-Where-Y’At-2.4_RacingAd-4.78x10.75.indd 1 1/23/23 4:44 PM NEW ORLEANS OPERA BOX OFFICE (504) 529-3000 boxoffice@neworleansopera.org www.NewOrleansOpera.org Madame Butterfly At the Mahalia Jackson Theater March 24, 2023 at 7:30 PM & March 26, 2023 at 2:30 PM TICKETS ON SALE NOW! and nobadance.com MOMIX in ALICE Moses Pendleton, Artistic Director SAT | MAR 11 | 7:30PM MAHALIA JACKSON THEATER NEW ORLEANS, LOUISIANA “A triumph of imagination, illusions, and special effects.” -The Wonderful World of Dance Sponsored by SOLD OUT • IN NOLA • SINCE 1993!
2023 Mardi Gras Parade Calendar February 1 WED 1 2 THU 3 FRI | | | 4 SAT | | | | 5 SUN | | | | | | 6 MON 7 TUE 8 WED 9 THU 1 0 FRI | | | | | | | | 1 1 SAT | | | | | | | | | | | | | 12 SUN | | | | | | 13 MON 14 TUE | | 15 WED | | | 16 THU | | | | 17 FRI | | | | | | 18 SAT | | | | | | | 19 SUN | | | | | | | | 20 MON | | | | 21 FAT TUESDAY | | | | | | | | | | SAT. FEBRUARY 11 PAWS OF OLDE TOWNE 10:00 A.M. LEGION OF MARS 11:30 A.M. PUSH MOW ............. 12:00 P.M. NEMESIS 1:00 P.M. TCHEFUNCTE 1:00 P.M. PONTCHARTRAIN ......... 1:00 P.M. CHOCTAW FOLLOWS FRERET FOLLOWS MADHATTERS. . . . . . . . . . . . . 5:00 P.M. KNIGHTS OF SPARTA . . . . . . . 5:30 P.M. PYGMALION FOLLOWS OLYMPIA 6:00 P.M. MON. FEBRUARY 20 PROTEUS ................ 5:15 P.M. ORPHEUS 6:00 P.M. CENTURIONS 6:30 P.M. FRI. FEBRUARY 10 CORK 3:00 P.M. OSHUN . . . . . . . . . . . . . . . . . . 6:00 P.M. CLEOPATRA FOLLOWS ALLA FOLLOWS EXCALIBER 6:30 P.M. SYMPHONY .............. FOLLOWS EVE 7:00 P.M. SUN. FEBRUARY 12 FEMME FATALE .......... 11:00 A.M. CARROLLTON 12:00 P.M. KING ARTHUR 1:00 P.M. DIONYSUS . . . . . . . . . . . . . . . 1:00 P.M. BARKUS . . . . . . . . . . . . . . . . . 2:00 P.M. TUES. FEBRUARY 14 THE CULINARY QUEENS OF NEW ORLEANS (TCQNO) .... 6:00 P.M. FAT TUESDAY TUE. FEBRUARY 21 ZULU 8:00 A.M. REX 10:30 A.M. ELKS ORLEANS ........... FOLLOWS CRESCENT CITY FOLLOWS ARGUS 10:00 A.M. ELKS JEFFERSON ......... FOLLOWS KREWE OF JEFFERSON FOLLOWS COVINGTON 10 FOLSOM ................ 2:00 P.M. WED. FEBRUARY 15 DRUIDS 6:15 P.M. NYX 6:45 P.M. THU. FEBRUARY 16 BABYLON 5:30 P.M. CHAOS . . . . . . . . . . . . . . . . . . 6:15 P.M. MUSES 6:30 P.M. FRI. FEBRUARY 17 BOSOM BUDDIES . . . . . . . . . 11:30 A.M. HERMES 5:30 P.M. D'ETAT 6:30 P.M. SELENE ................. 6:30 P.M. MORPHEUS 7:00 P.M. SAT FEBRUARY 18 BUSH 9 A.M. NOMTOC 10:45 A.M. IRIS ................... 11:00 A.M. TUCKS 12:00 P.M. ENDYMION 4:15 P.M. ISIS .................... 6:00 P.M. SUN. FEBRUARY 19 OKEANOS 11:00 A.M. MID-CITY 11:45 A.M. THOTH ................. 12:00 P.M. ATHENA 5:00 P.M. ATLAS FOLLOWS BACCHUS ................ 5:15 P.M. SAT. FEBRUARY 4 BILGE 12:00 P.M. POSEIDON . . . . . . . . . . . . . . . 6:00 P.M. KREWE DU VIEUX 6:30 P.M. FRI. FEBRUARY 3 TITANS 6:30 P.M. BOHÈME . . . . . . . . . . . . . . . . . 7:00 P.M. SUN. FEBRUARY 5 LITTLE RASCALS 12:00 P.M. ATHENIA 1:00 P.M. PEARL RIVER LIONS CLUB 1:00 P.M. 'TIT REX 4:30 P.M. KREWEDELUSION 7:30 P.M. Parade schedules and routes are subject to change. Please check WhereYat.com for updates. 28 Mardi Gras Manual | Where Y'at Magazine
The most popular question asked of our deputies during Mardi Gras season is “When is the parade going to get here?”
The Jefferson Parish Sheriff’s Office recognizes that Mardi G ra s i s a gre a t c e l e b ra t i o n e n joye d by a l l We w a n t everyone to have a good time and, most impor tantly, to be safe. Jefferson Parish has a history of successful Mardi Gras celebrations. Please follow these common sense rules and you too will help this year’s Mardi Gras be a very enjoyable and safe celebration And remember, always watch out for our children!
Please stand behind the barricades while the parade is passing, and keep in mind to not cross the roadway between members of any marching group It is also very dangerous to run between floats and vehicles while the parade is in progress.
Families who want to bring ladders for the kids may cer tainly do so; however, ladders cannot be placed in the street or in an intersection. All ladders must be placed behind the curb. The ladder must be one foot back behind the curb for every foot it is tall For example, a six-foot ladder must be six feet back behind the curb while a three foot ladder must be three feet back behind the curb. Also, ladders cannot be tied together.
No glass containers of any type are permitted within fifty (50) feet of any parade route As broken glass can pose a se riou s safe t y hazard, t his ordinance will be st rict ly enforced.
Please do not park in anyone’s driveway or park in a way that impedes the flow of traffic. Also, you must obey the no parking signs along the parade routes. Violators will be ticketed and towed at the owner’s expense
Mardi Gras floats are great to watch, but they can be very dangerous if you get too close, especially when they are moving. To prevent injuries, we do not permit riders to toss throws upon entering the disbanding areas. For your own safety, please stay clear of all parade disbanding areas
Ambulances, first aid stations, and lost children stations are located along all parade routes for the betterment of all parade goers
Please remember to provide a nametag with name and contact information for small children in the event you and your child become separated along the parade route
T h e J e f f e r s o n P a r i s h S h e r i f f ’s O ffi c e a n d o u r 1 , 4 0 0 e m p l o y e e s a r e a v i d s u p p o r t e r s o f M a r d i G r a s . I n consideration of the additional responsibilities placed upon our officers during this time, please obey an officer’s order to stop any disruptive behavior
We hope you enjoy Mardi Gras in Jefferson Parish The men and women of the Jefferson Parish Sheriff’s Office will do all they can to ensure that your Mardi Gras is a safe and pleasant one. Have a great time!

for
Paid
by the Committee to Elect Joseph Lopinto Sheriff
HAPPY MARDIGRAS
Sheriff Joseph Lopinto Jefferson Parish
CATCH IT IF YOU CAN
Rating the most coveted Mardi Gras parade throws
By Cynthea Corfah
The best kind of Mardi Gras throws are from the heart. During the parade season, formerly common objects transform into special collectables and Mardi Gras memorabilia.
The most popular throws are typically hand decorated, artsy items kept for show or functional items you can use like sunglasses, cups, napkins, and hats. Though everyone has their own personal favorites, let’s take a look at some of the most wanted Mardi Gras throws on a scale of “must have” to “nice to have.”
KREWE OF ZULU COCONUTS
Mardi Gras veterans go cuckoo for coconuts. These hand painted, drained, and shaved coconuts are a historic Mardi Gras throw. Dating back to 1910, the Zulu coconut has been a highly sought after throw from the very beginning. Like Muses shoes, coconuts are not thrown. They are handed from parade participants to the crowd. Each coconut is different. Some are painted with the year of the parade, while others are bedazzled and decorated with unique features like hair curlers, feathers, beads, and plastic wiggly eyes. The best part is you get to keep your coconut to remind you of Mardi Gras all year-round. They can be showcased on a bookshelf, desk or glass case (if you’re feeling fancy).

CYNTHEA CORFAH
30 Mardi Gras Manual | Where Y'at Magazine
The Zulu coconut is one of the most cherished throws



WhereYat.com | February 2023 31 MAKE THE GOOD TIMES COUNT Tennessee Whiskey, 40% ABV (80 proof). Distilled and bottled by JACK DANIEL DISTILLERY, Lynchburg, Tennessee. Jack Daniel’s and Old No.7 are registered trademarks. ©2023 Jack Daniel’s. All rights reserved. DRINK RESPONSIBLY. RESPONSIBILITY.ORG
KREWE OF MUSES SHOES



Being handed a decorated Muses shoe feels like receiving a blessing directly from God herself. For one, it’s a shoe. Who doesn’t love being gifted free foot candy? But they aren’t just any shoe. Muses throws one-ofa-kind, hand decorated, themed heels, and boots typically covered in glitter, feathers and other crafty embellishments. They are arguably one of the city’s most prized possessions. Probably because you don’t just get a shoe; you earn them. Krewe members pass by on the float, dangling the shoes over the crowd like fish bait. Whoever the shoe holder selects, brings home the trophy.
KREWE OF TUCKS PLUNGERS, TOILET BRUSHES, & TOILET PAPER
Outside of New Orleans, what other city gets excited about hand-decorated plungers, toilet brushes, and custom printed toilet paper? Tucks keeps the people laughing with their humorous, out-of-the-box throws. The toilet brushes and plunges are so adorned and colorful that you almost forget their original purpose. In the real world, using a plunger or toilet brush is hardly ever a good time. During a Tucks parade, it’s all you could ask for. And don’t forget the toilet paper. Locals often toss their toilet paper over tree branches, draping the parade route in beads and rolls of Tucks toilet paper.
KREWE OF CLEOPATRA CLEO CUPS


With the help of the Krewe of Cleopatra, you can have a kitchen cabinet fit for a queen. The krewe hands out bedazzled, glittered, and decorated acrylic glasses including wine glasses, goblets, champagne flutes, and tumblers. Like the famous coconuts and shoes, these custom Cleo cups aren’t handed out to everyone. The krewe hands out a limited amount, so if you’re lucky enough to get one, they are something to treasure.


KREWE OF ALLA GENIE LAMPS
Alla's hand-crafted genie lamps are works of art. Each genie lamp tells a story, starting with a similar base and decorated with as many trinkets and crafts that can fit atop the foundation. Krewe members are encouraged to bring a limited amount of lamps to hand out, so it may take more then three wishes to get one of these mystical creations. These limited ornate creations are bound to be the star of your Mardi Gras mantle—if you’re lucky enough to get one, that is.

32 Mardi Gras Manual | Where Y'at Magazine
FROM LEFT: SHOES—ROBERT WITKOWSKI (2); TOILET BRUSH—ROBERT WITKOWSKI; CUPS—CYNTHEA CORFAH; GE N IE LAM PS—FROM TOP: COURTESY KREWE OF ALLA; COURTESY TRACIE SMITH-HUGHES/ KREWE OF ALLA
lined with Mardi Gras beads, covered in glitter, have phrases written on the lenses, and have items stuck onto them like fake flowers, feathers, and pipe cleaners. Iris sunglasses never go out of style. If you catch a pair one year, you can save them and wear them again next parade season.



ALL PARADES
New Orleanians collect Mardi Gras cups like Pokemon cards. They are tangible, functional, and often dated collectables that commemorate each krewe’s parade theme for that year. Out of all of the Mardi Gras throws, the cups are something you can actually use on a daily basis. Think water cups, cups for tailgates, parade beers on-the-go, and dishware for children. It’s the gift that keeps on giving.

ALL PARADES DOUBLOONS



Remember as a kid when we used to collect the different quarters from every state? That’s kind of what happens during Mardi Gras with doubloons. Krewes throw various styles and colors of aluminum coins, known as doubloons, often stamped with the krewe’s name, year of the parade, and some of the krewe’s symbols or figures. Some frequent parade-goers collect doubloons religiously. They even string them together to turn them into handmade Mardi Gras wear like doubloon ponchos, vests, and jackets.


ALL PARADES
GLASS BEADS

There are plastic beads and then there are glass beads. Glass beads are the caviar of bead throws. They are often smaller necklaces that can be worn with everyday outfits and not thought of as disposable as plastic beads. On the parade routes, they are one of the most desired throws. They can be saved, gifted, or added to your jewelry collection.

WhereYat.com | February 2023 33
FROM LEFT: GLASSES—CYNTHEA
DOUBLOONS—GUSTAVO ESCANELLE / KREWE OF ENDYMION;
CORFAH; CUPS—ROBERT WITKOWSKI;
BEADS—MARDI GRAS SPOT
F abulous
ALL THE TIME
A NOLA History of Gay Mardi Gras
By Burke Bischoff
New Orleans’ Mardi Gras celebrations have been helping the city stand out on the world stage since the 1700s. While most people know about the parades and the costume balls, one relatively unknown side of NOLA Carnival, one specifically catered to the city’s LGBTQ community, has been around since at least the mid-20th century.
Today, New Orleans has a number of different Mardi Gras krewes that are specifically formed to include membership from the city’s local gay community. While NOLA is considered one of the most gayfriendly locations in America according to Metrosource and Hotels.com, that wasn’t always the case almost 65 years ago.
The story of New Orleans’ gay Mardi Gras was born during a time when people who did not openly identify as heterosexual faced legal discrimination and restrictions not only in the city, but throughout the United States. According to Edward McDaniel, who is the current ball captain and the 60th queen of the world’s oldest gay Mardi Gras krewe, the Krewe of Petronius, there were laws still on the books about homosexuality in the 1960s.
“Back then, being gay, you could be arrested; you could lose your apartment, your job,” McDaniel said.
It was in this climate that the Krewe of Yuga, which is considered to be the world’s very first gay Mardi Gras krewe, came into being. According to the Krewe of Petronius’ website, Yuga was formed in 1958 and held its first and only Carnival ball in 1961 in Jefferson Parish. The ball was ultimately raided by police and resulted in the arrests of nearly 100 individuals.
While the raid dismantled the city’s first gay krewe, it did not keep gay Carnival
celebrations down for long. One week before the fateful ball, several of Yuga’s members formed Petronius and held their first costume ball in Metairie in 1962. According to Petronius’ website, the krewe’s members were actually successful in getting a state charter and incorporated themselves as a legitimate Mardi Gras krewe in 1966, thus becoming Louisiana’s first officially recognized gay krewe.
After Petronius’ official recognition, more krewes began following suit like The Mystic Krewe of Amon-Ra in 1965 and the Krewe of Armeinius in 1968, opening the door for more LGBTQ locals to participate in Carnival like they never really could before.
“You have to remember that all of these groups are splinters of, originally, Petronius and Yuga,” McDaniel said. “So yeah, we’ve had to endure our trials and tribulations, but I think the success of a krewe is overcoming them and just enduring with time as society changes.”
Into the 21st century, more and more inclusive krewes have continued to appear and organize within New Orleans such as the Lords of Leather, the Mystic Krewe of Satyricon, and the Krewe of Mwindo. McDaniel says the krewes are always willing to support each other in times of need.


“I’ve always known them to be really supportive of each other,” McDaniel said.
“Each krewe is uniquely different. We work pretty much the same on who chooses the theme, who chooses the royalty. So I’ve never come across, personally, any animosity. If you need help, we’re more than willing to step in and help each other.”
One of the main defining attributes of a lot of the gay Mardi Gras krewes, much like many of the other krewes in New Orleans, are the annual balls that they put on. However, the gay krewes put their own unique stamps onto their bal masqués through the use of truly creative costuming.
“Gay Mardi Gras balls were a parody of straight balls,” McDaniel said. “So it’s just kinda poking fun and being larger than life.”
Like most balls, gay Carnival balls tend to have a different theme each year. For Petronius’ ball, which is usually held two or three weeks before Mardi Gras at the Frederick Sigur Civic Center in St. Bernard, McDaniel explains the krewe is looking to go back to its roots for 2023.
“The theme is ‘Lest We Not Forget’ because we’re looking at our history,” McDaniel said. “So what I did was I selected themes that the members could choose from and their interpretations of those themes. Not to copy what someone had done, but their interpretation. And it’s just our way of looking back at our history and paying respect to those who came before us. So we
did away with the big backpacks, or big back pieces as we like to call them, and we’re doing more Medicis and more headpieces and costumes.”
In addition to the costuming, McDaniel explains that Petronius’ ball captain selects a charity to donate to every year, which happens to be Covenant House for this year.

“It was important for me this year that I picked a charity that benefits the community as a whole and not just the LGBTQ community,” McDaniel said. “So that’s why I picked Covenant House.”
While the gay side of Mardi Gras might not be the most well-known aspect of NOLA’s world-famous Carnival celebrations, it is definitely there for those in the community that find it important.
“It’s really unique because we don’t care what other people think,” McDaniel said. “It’s basically, ‘It’s our krewe. It’s our family.’ So as long as we put on a ball that we feel is to our standards, we’re good with it.”
Despite facing many hardships like the AIDS crisis, Hurricane Katrina, the COVID-19 pandemic, and so much more, New Orleans’ gay Carnival krewes are still working hard to keep their traditions going every year. Hopefully they continue to do so for many more years to come.
“We move forward. That’s all we can do,” McDaniel said.
34 Mardi Gras Manual | Where Y'at Magazine ALL PHOTOS: COURTESY KREWE OF PETRONIUS
INTRODUCING

COSTUME CULTURE Making Mardi Gras Your Own
 By Frances Deese
By Frances Deese

Mardi Gras is a judgment-free zone, and many people want a standout look, but may be at a loss of where to start. Thanks to local experts, everyone can partake in a refresher course of how to get a full Mardi Gras look together.
NOLA Costume Culture then & now
The “anything goes” mentality for Mardi Gras that extends to its costumes and attire, can certainly be liberating. A time of year to dress how you please and to get truly creative offers a contrast to most people’s everyday lives. This, however, can be a double-edged sword. With so many sources of inspiration, it’s difficult to know what direction to take. Whether you are a new resident unsure of how to begin preparations, or a long-time dweller looking for new ideas, the city offers a number of resources. This compilation of expertise, knowledge and opinions, featuring

FROM TOP; PUBLIC DOMAIN;
WITKOWSKI
ROBERT
36 Mardi Gras Manual | Where Y'at Magazine









WhereYat.com | February 2023 37 ESCA P E RO OM 3102 MAGAZINE STREET GULFCOASTESCAPEROOM.COM Walk-ins Welcome
Bookit!


MARDI GRAS FOR THE MIND
March 9|10|11 2023






























THE NEW ORLEANS BOOK FESTIVAL will bring the world’s leading authors to TULANE UNIVERSITY’S uptown campus for a multi-day celebration! This FREE festival will provide an opportunity for authors and readers to interact with each other in one of the most vibrant and culturally diverse cities in the world. Be sure to join us for FAMILY DAY at the fest on SATURDAY, MARCH 11! Visit bookfest. tulane.edu for the full 2023 author lineup and updates!
bookfest.tulane.edu @nolabookfest
practical and creative breakdowns, offers a fun approach to costume creation.

The preservation of costume culture is an important resource to look towards. One institute and its founder helping to do so is the Mardi Gras Museum of Costumes and Culture. The museum was opened six years ago, and provides an intertwined educational and entertainment experience. Founder and operator, Carl Mack, has a collection of costumes that he has accumulated over the years. He also has knowledge of the holiday’s history, including the European traditions of Carnival, preLent. During this time, meat supplies were fully consumed, to avoid waste, and commoners poked fun at and pretended to be royalty through dress. The royal influence reigns today in the city, with traditional attire and Medici collars. However, the multicultural impact on the holiday should not be forgotten, such as its African, and Creole influences. The museum recognizes that the holiday is shaped by Mardi Gras Indians, and all the walking clubs.
An insightful reminder that Mack shared is that the elements of satire and decadence can still serve as a guide for the holiday today. Despite being the first to start doing green, gold, and purple reveler costumes, he is still in touch with how to create looks for the present-day holiday. His first tip is to start with a strong foundation, such as a bodysuit. More of his advice includes taking a note from the city—engineering and even thinking outside typical mediums. He also recommends E6000 glue as opposed to hot glue.
Once you’ve got this strong foundation, he recommends making it shine using mirrors, sequins, or glitter. A burgeoning trend he recommends is LED lights within a costume. Mack also offered the great advice that with Mardi Gras, there is always





38 Mardi Gras Manual | Where Y'at Magazine
ALL PHOTOS:
ROBERT WITKOWSKI

more to learn. To continue sparking inspiration, visit the Mardi Gras Museum of Costumes and Culture, located at 1010 Conti Street. Along with tours, they also offer mask decorating classes, and you can learn more by visiting themardigrasmuseum.


com

When it comes time to execute your costume and outfit once you have come up with a theme or concept, there are a number of great resources within the city. One that can help you truly stand out and fully assist with all your DIY needs is Nola Craft Culture. Owners




Lisette Constantin and Nori Pritchard both grew up in New Orleans, and that, along with being members of the Krewe of Muses, allowed them to see that there was a need for a city-centric craft supply store. Part of their mission is to offer a place where you can feel like a kid in a candy shop only surrounded with
The Independence Sicilian Heritage

colorful glitter, feathers, and sequins. This passion has translated to their vast number of offerings that extend beyond products— they know crafting is a therapeutic as well as cultural experience.

At the heart’s center of Nola Craft Culture is a mentality of collaboration, which can be a unique tip as well when creating Mardi Gras looks, so brainstorm with friends and family. They’ve aimed to create a low-pressure environment, even offering a community work space. Their craft workshops include: Glittering Skills,
Working with Transfers, Sculptural Design, Headdresses & Fascinators, UV Resin, Polymer Clay Design, and Sewing 101. The shop offers an abundance of products and online shipping. Additionally, they have a local artisan’s market and carry local brand Elektra cosmetics for those looking to add to their overall look. Constantin and Pritchard share that it’s important to start with materials that speak to you, and that the first step is a leap of faith. The overall theme should be what brings you joy. Overall, they recommend moving forward with whatever speaks to you, and channeling the spirit of Mardi Gras how you see fit. Learn more by visiting nolacraftculture.com
Once the holiday rolls around the corner, everyone is excited to celebrate but the lead up and choosing how to stylize yourself can produce butterflies in your stomach. A great place to start for foundations is thrift and vintage shops, as they are not only affordable, but also have distinctly unique finds. Some great vintage shops include: Swamp Rag’s Vintage, Miss Claudia’s Vintage Clothing & Costume, Glue, Funky Monkey New Orleans, and Blue Dream. As per thrift shops, some top ones in the city include: Bridge House Thrift Store, Junk’s Above, and Goodwill Industries of Southeastern Louisiana. Even if you don’t have a full costume closet, you may already own a number of things that can be utilized. This Mardi Gras, don’t be afraid to put your own spin on a costume as you see fit.
40 Mardi Gras Manual | Where Y'at Magazine MARCH 22-25, 2023 HILTON NEW ORLEANS RIVERSIDE CONTEMPORARY ARTS CENTER • BOURBON BRAWL • VIP PARTY • BOURBON DINNERS • 30 EDUCATIONAL SEMINARS • VIP GRAND TASTING ACCESS • 20+ RESTAURANTS FROM NEW ORLEANS AND GULF COAST • 2-NIGHT GRAND TASTING TICKETS AND ROOM RESERVATIONS WWW.NOBOURBONFEST.COM LOUISIANA’S PREMIER BOURBON FESTIVAL Downtown
Independence
MARCH 10-12, 2023 Delicious Food Great Music Family Fun Meatball Toss Spaghetti eating contest Carnival Rides Parade Win A Trip To Sicily
Independence, La
Sicilian Heritage Festival
Featuring Lena Prima
indysicilianfest.com
Festival
FROM LEFT: FRENCES DEESE; ROBERT WITKOWSKI
Collective costume crafting
Tucks Can’t Drive 55 Tucks Can’t Drive 55
TUCKS 55TH ANNUAL PARADE | SATURDAY, FEBRUARY 18, NOON





2,300 members on 36 super floats and 7 new floats • Marching Bands & Equestrian Teams

King & Queen Tucks LV



King Todd Fujimoto
Todd Fujimoto is a graduate of Tulane’s A.B. Freeman School of Business and is the Deputy, Asst. Chief of Staff G-4 (Logistics) at Marine Forces Reserve Headquarters. Todd will be reveling with the Krewe of Tucks for his 13th year and is the husband of Queen Tucks XLV…as well as the co-captain of the Tucksedeauxs float.
Queen Sheri Bleuler

Ms. Bleuler is a graduate of Tulane University where she earned a B.A. in Media Arts along with a minor in Art. Sheri built a krewesignature float – The Tucks Brothel as well as designing three additional signature floats. Sheri intentionally purchases hand-made throws from other local artists to toss off the Queen’s Float.

WhereYat.com | February 2023 41
IT’S A RELIGIOUS HOLIDAY: LENT EVE
Although parades are full of revelers of all denominations in or around the processions, Mardi Gras, and the time leading up to it, is inherently a Catholic celebration. In liturgical timelines, Carnival begins after the twelfth day of Christmas—the Epiphany on January 6. Much like Halloween, Mardi Gras marks the day to blow off steam before a restrictive holy day. Carnival continues until the day before Ash Wednesday, which is the start of Lent, the most solemn time in the Catholic church prior to Easter. Lent represents Jesus’ fasting in the desert before being crucified. Mardi Gras—the French translation of “Fat Tuesday”—is the last day to indulge in excess before the 40-day fast begins at midnight on Ash Wednesday.
NOBODY DOES IT BETTER
While Mardi Gras often encapsulates celebrating the Carnival season of masquerade parties and over indulgence, the term refers to a single day. The partying is recorded to have been celebrated since Medieval times in heavily Catholic countries, long before the U.S. was “discovered.” These include Italy, Germany, Russia, Brazil, Trinidad and Tobago, Poland, United Kingdom, and, of course, France. Rio de Janeiro in Brazil may be one of the few Mardi Gras celebrations to rival the Big Easy’s multiweek fete.
UNMASKING MARDI GRAS
12 Things People [Prbly]
Don’t Know About NOLA's Carnival Season
PIECE OF CAKE
Carnival begins on the Epiphany, when the three wise men arrived at the manger to recognize Jesus as the Christ Child. Also known as King’s Day, it should be no surprise that the Christmastime pastry became known as the king cake, complete with a hidden plastic baby.
King cakes are decorated with the Mardi Gras colors of purple, green, and gold frosting. Some believe the colors represent each of the three kings. Others say, perhaps, they represent their three gifts to Jesus: myrrh, an embalming oil (purple as the color of death); frankincense, an incense (green representing God); and gold (God’s kingship on earth). The reality is that the Rex Organization used the Romanoff family colors in honor of the visiting Russian Czar in 1872, they just stuck: justice (purple); faith (green), and power (gold).

The baby? The Virgin Mary’s newborn child, of course. Which might actually make it a birthday cake.
MAKING THE BUCKET LIST
By Robert Witkowski
While much of the country hunkers down under a blanket of snow after the start of the new year, the City that Care Forgot celebrates with masquerade balls, a whole lotta music, and even more parades. But this preeminent bucket-list party still has much that many revelers may not know.
BETTER TO GRANT PERMISSION
From the birthplace of Mardi Gras in the U.S., Mobile’s mayor issues annual proclamations to “allow” New Orleans to celebrate Mardi Gras.

Promoting Mardi Gras was one of the earliest tourism campaigns. After the Civil War, the former-Confederate port city was still struggling to recover economically during Reconstruction and was desperate to re-engage trade with the northern cities. Recognizing an opportunity, New Orleans media and word-of-mouth campaigns began driving interest in the event, bringing Northern dollars down south, bolstering the economy. If you throw it, they will come.
MADE IN TULANE
SWEET HOME ALABAMA
When discovered in 1699 by the French pioneering Le Moyne brothers on Lundi Gras, “Louisiane” was originally comprised of parts of eastern Texas, Alabama, Mississippi, and, of course, Louisiana. In 1702, its first capital was established in Mobile, AL. Boeuf Gras (another name for Fat Tuesday referring to a fatted calf) was observed in Mobile the following spring of 1703. New Orleans was established 16 years later; however, the holiday was not regularly celebrated in the Crescent City until the 1730s. A Louisiana state holiday as of 1875, NOLA has eclipsed Mobile as the epicenter of Fat Tuesday revelry.
“In previous years, we have presented a tongue-in-cheek proclamation giving New Orleans and other cities permission to conduct their festivities,” confirmed Mobile spokesperson, Jason Johnson. “This was always done in the spirit of revelry and with respect for New Orleans.”
There is no record of New Orleans ever refusing the honor.
THE FRENCH CONNECTION
Beyond the Gulf region, St. Louis, MO and Portland, ME are intertwined with Louisiana’s historical colonial French heritage. As a result, both cities also officially recognize Mardi Gras.

Some say that a group of Tulane students in colorful costumes, dancing in the streets on Mardi Gras Day in 1827 was the origin of parades, with the first official parade in 1837. The oldest established krewe, The Mistick Krewe of Comus, first meandered along Julia S. to St. Charles Ave. in 1857. New Orleans parades haven’t been the same since.
HAVE A BALL
Author Arthur Burton LaCour notes the Comus Ball in 1857 on Gravier Street as New Orleans’ first Mardi Gras ball. Since that initial party, MardiGras. com approximates that 137 Carnival balls are scheduled annually, kicking off the season with the Twelfth Night Ball each January 6, by—who else?— the Twelfth Night Revelers. If you are invited, it’s important to note that despite the parades featuring colorful and outlandish costumes and masks, the corresponding balls are generally black tie.
42 Mardi Gras Manual | Where Y'at Magazine FROM LEFT: COURTESY MOBILE CARNIVAL MUSEUM; CITY OF MOBILE; WHERE Y'AT STAFF





















































































THE MASKED PARADER
Even before selfies and social media, respected pillars of New Orleans society still did not wish to have their drunken indiscretions during Mardi Gras celebrations made public. So a law was passed to protect the guilty: “Wearing of masks, hoods, or other facial disguises in public places prohibited…exceptions; permit to conduct Mardi Gras festivities.” This, along with N95 medical masks, made masking legal.

NO MARDI GRAS FOR YOU
While Fat Tuesday cannot be canceled as a holiday any more than Ash Wednesday or the subsequent Easter, the revelry can be. The 2021 pandemic was only the latest of 14 times New Orleans stopped letting the good times roll.


1979 New Orleans Police strike
1951 Korean War
1942-1945 World War II
1919 Spanish Flu pandemic
1918 WWI
1879 Yellow Fever
1875 White Supremacist unrest

1862-1865 Civil War

THE MEANING OF LIFE
The Intergalactic Krewe of Chewbacchus is a legally recognized religion in Louisiana, with the late Peter Mehew (who played Chewbacca in the Star Wars franchise) as their "patron saint." This non-profit designation earns the krewe charitable legal taxexempt status in Louisiana—as well as getting married by a wookie— according to one of a founding Menin-Black members. This subsequently helps ensure membership dues will forever remain $42, which any Hitchhikers Guide to the Galaxy fan will tell you, is the answer to the meaning of life—unfortunately no one knows the question. But all are welcome, so members do not need to convert to the sci-fi krewe. However you roll, may the force be with you.
44 Mardi Gras Manual | Where Y'at Magazine
FROM TOP: WIKIMEDIA COMMONS / PUBLIC DOMAIN; BRIAN LIN/FLICKR CC; WIKIMEDIA COMMONS / PUBLIC
DOMAIN
1873 Comus Ball followed the grand parade
A Union blockade closed New Orleans in 1862, cancelling Carnival through the Civil War
Mardi Gras anonymity







OF
PURPLE, GREEN & GOLD
By Brooke Adams
LGBTQIA+ Friendly Mardi Gras Events
There are parades, parties, and events nearly every weekend. All through the Mardi Gras season, good times roll and the beads get thrown around like, well, beads at Mardi Gras, and the events around town are countless.
Just like our city, the masses of tourists flocking to New Orleans for Mardi Gras are diverse. Always a true Southern host, our city welcomes everyone with open arms, and events for everyone, including the queer community. The spirit of Mardi Gras welcomes the extravagant, the peculiar, and the provocative. No one understands how to encompass all three quite like the LGBTQIA+ community. The queer community has events throughout the season that provide a safe space to be out, loud, and proud, while also celebrating Mardi Gras.
GRRLSPOT MARDI GRAS PARTY
February 4
After the Krewe du Vieux Parade
GrrlSpot is a semi-monthly pop-up queer and lesbian bar and event space in New Orleans, with their biggest events during Mardi Gras, Pride, Decadence, and Halloween. GrrlSpot’s mission is to create an exciting and welcoming space for folx of all genders and to support local artists and small businesses in New Orleans. GrrlSpot began in the aftermath of Hurricane Katrinaa in 2005 as a small meet up for queer women returning to New Orleans. Eventually, the number of folx showing up to these meet-ups grew to be over 100 people. The organizers started working with bars and venues ahead of time, making sure there were enough bartenders and other staff to accommodate the crowds. Now these events often host dancers, DJs, and other entertainment. This year, GrrlSpot will be hosting a party following the Krewe du Vieux parade, a local favorite for the saucy and audacious costumes and themes.
THE PHOENIX BAR
Balcony Bead Toss and Lords of Leather
Mardi Gras Ball Afterparty
Saturday, February 18 / TBD
The Phoenix Bar is a well known gay leather bar in New Orleans that hosts queer and leather oriented events throughout the year. Every Mardi Gras, the Phoenix hosts two special events: their Balcony Bead Toss and the

Lords of Leather Mardi Gras Ball Afterparty. Both of these events are free, and the bar remains open to the public. This year, the Balcony Bead Toss will be held on Saturday, February the 18 from 7 p.m. to 10 p.m. This bead toss is hilariously saucy, with prized throws including specially decorated adult novelties which resemble a part of the male anatomy. Following the Mardi Gras Ball for the Lords of Leather, the attendees and friends make their way to the Phoenix to keep the good times rolling. This afterparty is a great way to get a taste for the gay Mardi Gras krewes and their extravagance.
THE GOLDEN LANTERN BAR
TBD
The Golden Lantern is one of the oldest gay bars in New Orleans, having opened in 1964. The Golden Lantern is an inclusive community gathering space in the French Quarter that is the original home of Southern Decadence, an annual six-day event held in New Orleans during Labor Day Weekend. The local bar hosts events throughout the year featuring drag shows, live music, and great drinks. While they are known for the birth of Southern Decadence, they also host events throughout the Mardi Gras Season.
THE BOURBON STREET AWARDS
Mardi Gras Day–12pm
Corner of St. Ann and Dauphine Streets
Last but certainly not least, one of the most spectacular LGBTQ+ Mardi Gras events held every year is the Bourbon Street Awards. Each year, the crowds gather at the intersection of St. Ann and Dauphine Streets for one of the most extravagant and extraordinary costume contents ever to be seen. In years' past, celebrity emcees have graced the stage to entertain the gayest and rowdiest crowds of the year. This is an event that is truly unforgettable, with cash prizes being handed out to the winners, whose costumes cost hundreds and thousands and exhausting hours to create. The categories for the contest include best drag, best group, best leather, and best overall costume.
Whether you’re looking for glitz and glamor, or sexy and extravagant, New Orleans has it all. These LGBTQ+ friendly events provide a safe space to celebrate Mardi Gras in style, whatever that style may be.

46 Mardi Gras Manual | Where Y'at Magazine
When most people think of Mardi Gras, the first things that come to mind are beads, booze, and boobs. The promise of the intoxicating trio is what draws in over a million tourists every year. What many tourists don’t know though is that Mardi Gras is a marathon, not a sprint.
CLOCKWISE TOP FROM LEFT: BROOKE ADAMS; COURTESY KARINA RAMIREZ / @KARINA_RAMIREZ_PRODUCTIONS; BOURBON STREET AWARDS / FACEBOOK
RAINBOW
Debbie with a D, Best Drag Category













WhereYat.com | February 2023 47 Downtown Property and Business Owners: Go to downtownnola.com to learn about grants for façades, lighting, signage, graffiti assistance, and more! Let Our Krewe Help Yours! The DDD’s Public Safety Rangers will accompany anyone anywhere Downtown free of charge! Call or Text 504-415-1730 from 6 am – 10 pm. norta.com/mardigras
FRIDAY, FEBRUARY 3
Apple Barrel Bubbles Brown
Bacchanal David Sigler, Harmanouche
Banks Street Bar Kind Hearted Strangers
Bayou Bar Peter Harris Trio
Blue Nile Kermit Ruffins
Cafe Negril Dana Abbott Band, Jamey St Pierre
DMACS Sierra Green, Zach Smallman
Deutsches Haus Damenchor, Saengerchor
Fillmore New Orleans Flogging Molly
French Market - Dutch Alley Sincopado Trio
Gasa Gasa Moccasyn
House of Blues Pandora’s Box
Hyatt Regency Liquid Blue
Irene’s Monty Banks
Joy Theater Carnivoid 2023
Mahalia Jackson Theater Louisiana
Philharmonic Orchestra
NOPSI Hotel Matt Lemmler
New Orleans Jazz Museum Matt Booth
Orpheum Theater Death Cab For Cutie
Republic NOLA bàwldy, Donny
Saturn Bar Bon Bon Vivant, Dusky Waters
Sheraton New Orleans Hotel Jazz @ the Blue
Dog
Smoothie King Center Legendz of the Streetz
Tour Reloaded
Spotted Cat Chris Johnson Band
St. Michael’s Episcopal Church Father Ron and
Friends
The Rabbit Hole Body Language, Brass Queens
Tipitina’s Preservation Hall Jazz Band
SATURDAY, FEBRUARY 4
Bacchanal Juan Tigre, Pete Olynciw
Balcony Music Club B3DLive
Bookoo Mega Ran
Cafe Negril New Orleans Rug Cutters, The
Amadeezy, Sticktalk
Toulouse Theatre Karneval!

SUNDAY, FEBRUARY 5
Bacchanal Noah Young Trio, Tangiers Combo
Cafe Negril John Lisi, Vegas Cola
Constantinople Stage Desert Nudes
DMACS Greg Afek

Gasa Gasa Prevail 19:21
House of Blues The Parish Soulfly
Republic NOLA DJ Poppa, Rude Jude
Saenger Theatre Chris D’Elia
Spotted Cat Songbird Sundays
The Hangar Ott
The Howlin Wolf Hot 8 Brass Band
The Rabbit Hole 79ers Gang
Tipitina’s Bruce Daigrepont Cajun Band
MONDAY, FEBRUARY 6
30/90 Dapper Dandies, Natural Bone Killers
AllWays Lounge Chris Beroes-Haigis, Christien
Bold
Apple Barrel Mark Appleford
Bacchanal Byron Asher
Bamboula's The Melataun’s
Breakaway's R&B Sariyah I Dan
Cafe Negril Cristina Kaminis
Chickie Wah Wah Papa Mali
Columns Hotel James Singleton, Joe Ashlar
d.b.a. Secret Six Jazz Band
Dos Jefes John Fohl
Fritzel's Jazz Club
Mahogany Jazz Hall Tom Hook, Original Tuxedo Jazz Band
Man Ray Records Vinyl Williams
Maple Leaf Alvin Ford Jr.
MRB Ben Buchbinder

Preservation Hall Preservation Brass
Sierra Green Show
DMACS ESP
Favela Chic Brass Queens
Felix’s Restaurant Rhythm & Rain Trio
Fillmore New Orleans Incubus
Fountain Lounge Monty Banks
Gasa Gasa Sam Bet
House of Blues 90’s: Midnight Memories
Mahalia Jackson Theater Louisiana
Philharmonic Orchestra
Republic NOLA Krewe Du You
Saenger Theatre Frankie Valli & The Four
Seasons
Sheraton New Orleans Hotel Jazz @ the Blue
Dog
Spotted Cat Soul Brass Band
The Howlin Wolf Fete Taboo
The Rabbit Hole secret handshake ft.
Republic NOLA STRFKR
Sidney's Saloon No Quarter Shanty Krewe
TUESDAY, FEBRUARY 7
AllWays Lounge Sw33theartbreak
Bayou Bar Peter Harris Quartet
Cafe Negril The Super-Most-Fantastic-Blues-NSuch Jam
Gasa Gasa PON DE RIRI: Rave to Rihanna
House of Blues Token, Ben Reilly
Irene’s Monty Banks
Mahalia Jackson Theater The Simon & Garfunkel Story
New Orleans Jazz Museum Arrowhead Jazz Band, Treme Lafitte Brass Band
Spotted Cat Chris Christy Band, Smoking Time Jazz Club
The Rabbit Hole Rebirth Brass Band
48 Mardi Gras Manual | Where Y'at Magazine
WhereYat.com CONTACT GROUP SALES TODAY: 504.948.1285 or GROUPSALES@FGNO.COM • Multiple private event spaces and suites • Delicious speciality menus available • Experience thrilling live thoroughbred races • Take pictures in the Winner’s Circle • Ideal for decorating parties, brunch, luncheons and more! We’ve got the perfect spot to entertain your whole group before parade day: GATHER YOUR KREWE AND LET THE GOOD TIMES ROLL. FGNO-45586-GroupSales-MardiGras-WhereYat-2.4-Ad_4.78x10.75.indd 1 1/30/23 12:44 PM ANDREA BOCELLI AT THE SMOOTHIE KING CENTER World famous Italian tenor Andrea Bocelli will be doing his first ever New Orleans performance with the Louisiana Philharmonic Orchestra. His song “Con te partirò” is one of the best-selling music singles of all time. Saturday, February 11, 8 p.m., Tickets start at $81, smoothiekingcenter.com ASM GLOBAL
MUSIC CALENDAR















Yeah You Right! MUSTBE 21+ SATURDAY, MARCH 18 2-7 PM • LAFRENIERE PARK CRAFT BEER • FOOD TRUCKS • HOME BREWS BENEFITING NOLAONTAP.ORG LIVE MUSIC ON THREE STAGES! GEORGE PORTER JR. & RUNNIN’ PARDNERS JON CLEARY & THE ABSOLUTE MONSTER GENTLEMEN HONEY ISLAND SWAMP BAND • THE RUMBLE MARC STONE WITH SPECIAL GUEST JOHN MOONEY TICKETS ON SALE NOW! BREWTALITY WRESTLING • DOGGIE DRAG SHOW ZONY MASH STAGE CHOPPA WITH SPECIAL GUESTS ABITA BEER STAGE MODELO ESPECIAL STAGE 985.373.9171 ROOFING ST. PAWTRICK’S DAY VIP!
MUSIC CALENDAR
Toulouse Theatre Stephen Sanchez
WEDNESDAY, FEBRUARY 8
Banks St. Bar Marc Stone
Bayou Bar Peter Harris Trio
Cafe Negril The Budz, Colin Davis
Chickie Wah Wah Jon Cleary
DMACS Paul Faith
House of Blues Bass Drum of Death
Irene’s Monty Banks
Le Bon Temps Roulé The Talismen
New Orleans Jazz Museum Molly Reeves
Quartet
Spotted Cat Chris Christy Band, Shotgun Jazz Band
THURSDAY, FEBRUARY 9

Bayou Bar Peter Harris Quartet
Bombay Club Shawan Rice
Cafe Negril Piano Man ‘G’, Sierra Green
DMACS Paggy Prine, Pizza Man’s Fam Jam
Fillmore New Orleans Subtronics
Gasa Gasa Favorite Friend
Irene’s Monty Banks
Le Bon Temps Roulé The Soul Rebels
Spotted Cat Chris Christy Band, Jumbo Shrimp
Jazz Band
Tipitina’s Highly Suspect
FRIDAY, FEBRUARY 10
Bayou Bar Peter Harris Trio
Blue Nile Kermit Ruffins
Cafe Negril Bon Bon Vivant, Dana Abbott Band
Chickie Wah Wah Alex McMurray
Civic Theatre Bal Kanaval
DMACS Jamey St. Pierre, Sam Forshey
El Cucuy Dusky Waters
Fillmore New Orleans Emline Ball
French Market - Dutch Alley Manuel Arteaga’s Trio
Gasa Gasa Incubators
House of Blues Alaska 5000
Irene’s Monty Banks
Le Bon Temps Roulé Sneezy
MRB Bar & Kitchen Anna Laura Quinn
NOPSI Hotel Matt Lemmler
Santos Bar Marina Orchestra
Sheraton New Orleans Hotel Jazz @ the Blue
Dog
Skeeta Hawk Brewing Father Ron
Southport Hall Eyehategod, Green Gasoline


Spotted Cat Chris Johnson Band
The Rabbit Hole Valhalla Ball
Tipitina’s Lucero
SATURDAY, FEBRUARY 11

Bacchanal Jasen Weaver Trio
Cafe Negril Jason Neville, New Orleans Rug
Cutters
Chickie Wah Wah Gal Holiday
DMACS Sean Hobbes, Jon Sheckler
Eedo’s Restaurant Krewe of West Africa
Culture Festival
Fountain Lounge Monty Banks
Gasa Gasa Panama Papers
Hi Ho Lounge Zita, Drab
Joy Theater LSD Clownsystem
Le Bon Temps Roulé Very Cherry
Maple Leaf Bar John “Papa” Gros
Old Road Coffee Father Ron, Robert Eustis
Rock n Bowl The Boogie Men
Royal Frenchmen Hotel Saint Mercedes, Medicinal Harmony
Smoothie King Center Andrea Bocelli
Spotted Cat Panorama Jazz Band, Shake’em Up
Jazz Band
The Blue Crab Restaurant Andrée & the
Giants
The Rabbit Hole Mark Farina
The Sugar Mill Mannie Fresh, G-Eazy
Tipitina’s Lost Bayou Ramblers
SUNDAY, FEBRUARY 12
AllWays Lounge After Hours Local Musician
Jam
Bacchanal Wine Noah Young Trio, Tangiers
Combo
Cafe Negril John Lisi, Marina Orchestra
DMACS Daniel Louis
Le Bon Temps Roulé Dr. Lo Faber
Old Point Bar Gregg Martinez
The Howlin Wolf Hot 8 Brass Band
The Rabbit Hole Emily Arceneaux
The Tigermen Den James Singleton Quartet
MONDAY, FEBRUARY 13
30/90 Piano Man G
Apple Barrel Mark Appleford
Bamboula’s The Melataun’s
Buffa’s Doyle Cooper Trio
Cafe Negril Cristina Kaminis
Columns Hotel Stanton Moore, James
Singleton, David Torkanowsky
D.B.A. RAM - Haitian Voodoo Rara Music
Dos Jefes John Fohl
DMACS Monday Blues Jam
Gasa Gasa Free Live Band Karaoke
Tipitina’s Kevn Kinney, Amy Ray
TUESDAY, FEBRUARY 14
Bacchanal Jasen Weaver Trio, Charlie Halloran
Bayou Bar Peter Harris Quartet
Fillmore Elle King, Red Clay Strays
Irene’s Monty Banks
Jefferson Performing Arts Center The Black
Jacket Symphony
Loyola University Amina Scott & Cindy Scott
New Orleans Jazz Museum Arrowhead Jazz
Band
Santos Bar Jenny Don’t
Spotted Cat Chris Christy Band,
Smoking Time Jazz Club
The Rabbit Hole
Rebirth Brass Band
Zony Mash Helen
Gillet, Jason Marsalis
WEDNESDAY, FEBRUARY 15
Bayou Bar Peter Harris Trio
Cafe Negril The Budz, Colin Davis
Chickie Wah Wah Jon Cleary
Gasa Gasa COMP4NY
Hi Ho Lounge Brian Haas, James Singleton
Irene’s Monty Banks
New Orleans Jazz Museum The Kitchen
Spotted Cat Chris Christy Band, Shotgun Jazz Band
THURSDAY, FEBRUARY 16
30/90 Big Mike & the R&B Kings
Bamboula’s Wolfe John’s Blues
Bayou Bar Peter Harris Quartet
Bombay Club Shawan Rice
Cafe Negril Piano Man ‘G’, Sierra Green
Carrollton Station Duane Bartels Band, Prey For Neighbors, The Uneven Floors
Deutsches Haus Liederkranz German Sing-along
DMACS Paggy Prine, Pizza Man’s Fam Jam
Dos Jefes Ashley’s Other Animal
Fritzel’s Jazz Club Fritzel’s All-Star Band ft.
Kevin Ray Clark
Gasa Gasa The Bloomies
House of Blues The Silver Lining Serenaders
Irene’s Monty Banks
Jazz Playhouse Brass-A-Holics
Joy Theater George Porter Jr., Runnin’ Pardners
Kitchen Table Cafe Dr. Mark St. Cyr Trad Jazz
50 Mardi Gras Manual | Where Y'at Magazine For up-to-date listings visit WhereYat.com


















WhereYat.com | February 2023 51 // COMING SOON // COMING SOON // COMING SOON // 02/05 05/04 05/05 05/06 02 02/17 02/18 02/14 02/28 03/01 03/04 03/05 03/10 10/02 HOUSE OF BLUES THE FILLMORE BIG MOMMA'S AT HOB BIG MOMMA'S AT HOB THE FILLMORE HOUSE OF BLUES THE FILLMORE PARISH AT HOB HOUSE OF BLUES PARISH AT HOB HOUSE OF BLUES THE FILLMORE THE FILLMORE THE FILLMORE









52 Mardi Gras Manual | Where Y'at Magazine
FEBRUARY 10-11, 2023









WhereYat.com | February 2023 53
GRAS SATURDAY, FEBRUARY 11
FAMILY
LIVE MUSIC
Band
Le Bon Temps Roulé The Soul Rebels
Madame Vic’s Otra
Maple Leaf Keiko Komaki
New Orleans Jazz Museum Kyle Roussel
Palm Court Jazz Cafe Duke Heitger, Tim
Laughlin, Crescent City Joymakers
Pour House at District Lynn Drury

Rock n Bowl Chubby Carrier & Bayou Swamp
Band
Royal Frenchmen Hotel & Bar Lex
Warshawsky Quartet
Spotted Cat Chris Christy Band, Jumbo Shrimp
Jazz Band
Tipitina’s TBC Brass Band, Big Freedia

The Maison Bettis & 3rd Degree
Three Keys Helen Gillet
FRIDAY, FEBRUARY 17
30/90 Tamarie T, Thee Elektra Kumpany
Bamboula’s Paggy Prine

Bayou Bar Peter Harris Trio
Blue Nile Amigos Do Samba
Angelamia Bachemin
MRB Ben Buchbinder
NOPSI Hotel Matt Lemmler
New Orleans Jazz Museum Seven Cities Brass
Band
Old Point Bar Tyron Benoit
Orpheum Theater Buck Meek, Big Thief
Palm Court Jazz Cafe Kevin Louis, Yolanda
Robinson, Palm Court Jazz Band
Pour House at District Tiffany Pollack, Brandon
Brunious
Pour House at Jefferson Gwen & the Old Man
Rock n Bowl Ryan Foret & Foret Tradition
Roosevelt Hotel Antoine Diel, Josh Paxton
Royal Frenchmen Hotel & Bar Khris Royal

Sheraton New Orleans Hotel Jazz @ the Blue Dog
Smoothie King Center Anita Baker
Spotted Cat Chris Johnson Band
Sydney’s Saloon Deathproof


The Rabbit Hole Replicant
The Maison Pocket Chocolate
STS9 AT THE FILLMORE NEW ORLEANS
Instrumental band Sound Tribe Sector 9 (STS9) is sure to put on a unique and lively show at The Fillmore. The band’s interesting sound mixes live rock instruments with electronic music and has an emphasis on group improvisation.

Friday, February 17 & Saturday, February 18, 7 p.m., Tickets start at $49.50, livenation.com

BMC Renee Gros
Bratz Y’all! Johnny Burgin
Buffa’s Cricket & the 2:19
Cafe Istanbul Anna Moss, Gina Leslie
Cafe Negril Higher Heights, Jamey St Pierre
Carrollton Station Marina Orchestra
DMACS The Joey Houck Band, The John Krupa
Project
Deutsches Haus Damenchor Deutsches Haus, Saengerchor Deutsches Haus
Dos Jefes Tom Fitzpatrick
Fillmore New Orleans STS9
French Market - Dutch Alley Geovane Santos
Trio
Fritzel’s Jazz Club Fritzel’s All-Star Band ft.
Kevin Ray Clark
Gasa Gasa Chupacabra, Killer Whale
Hey Cafe I Got Da Baby with Valerie Sassyfras
House of Blues Or Shovaly Plus
Irene’s Monty Banks
Jazz Playhouse The Wolfe Johns Blues Band
Kerry Irish Pub Patrick Cooper
Le Bon Temps Roulé Colin Davis & Night
People
Madame Vic’s Gingerbread, Vincent Marini,
SATURDAY, FEBRUARY 18
Blue Nile Big Sam’s Mardi Gras Birthday Bash
Cafe Negril Bon Bon Vivant, New Orleans Rug

Cutters
DMACS Concrete Confetti
Fillmore STS9
Gasa Gasa Jimmy Wooten, Nik Parr
Metropolitan JVNA, Deadmau5
Republic NOLA Eric Bellinger
Sheraton New Orleans Hotel Jazz @ the Blue
Dog
Spotted Cat James Martin Band
The Rabbit Hole Egyptian Lover
Tipitina’s Galactic, Anjelika “Jelly” Joseph
SUNDAY, FEBRUARY 19
Bacchanal Noah Young Trio, Tangiers Combo
Blue Nile New Orleans Nightcrawlers
Cafe Negril John Lisi, Vegas Cola
D.B.A. John “Papa” Gros, Big Chief Monk
Boudreaux
DMACS Amanda Pruitt
Le Bon Temps Roulé The Soul Rebels
Republic NOLA ZOMBOY
Spotted Cat Music Club Songbird Sundays
54 Mardi Gras Manual | Where Y'at Magazine
MUSIC CALENDAR
2/8 8 PM THE TALISMEN 2/9 11PM THE SOUL REBELS 2/10 11 PM SNEEZY 2/11 11 PM VERY CHERRY 2/12 8 PM DR. LO FABER 2/16 11 PM THE SOUL REBELS 2/17 11 PM COLIN DAVIS & NIGHT PEOPLE 2/18 11 PM TBA 2/19 8 PM DR. LO FABER 2/19 11 PM THE SOUL REBELS 2/23 11 PM THE SOUL REBELS 2/24 11 PM RUSSELL BATISTE & FRIENDS 2/25 11 PM THE MISSISSIPPI SHAKEDOWN 2/26 8 PM DR. LO FABER CELEBRATING 44 YEARS! Thank You For Your Continued Support! Book Your Next PrivateHere!Party KITCHEN OPEN 11 AM – 10 PM DAILY Join Us for Great Burgers, Sandwiches, Empanadas, & More! TRY OUR NEW QUEEN CAKES! YOUR UPTOWN PARADE HEADQUARTERS! 4801 MAGAZINE ST. * 897-3448 LBTRNOLA.COM
STS9BAND
The Howlin Wolf Hot 8 Brass Band
The Rabbit Hole Bass Church, Worst Behavior Recs

Tipitina’s Anders Osborne
MONDAY, FEBRUARY 20

Blue Nile The Soul Rebels
Cafe Negril Cristina Kaminis
DMACS Monday Blues Jam
Fountain Lounge Monty Banks
Maple Leaf Bar New Orleans Suspects

Metropolitan Nightclub CID, WAX MOTIF







Morial Convention Center Orpheuscapade
Republic NOLA MIJA

Spanish Plaza Riverwalk’s 37th Annual Lundi
Gras



The Rabbit Hole Bass Church x Worst Behavior
Tipitina’s Big Chief Juan Pardo, Galactic
TUESDAY, FEBRUARY 21


30/90 Hotline, Neicy B & Kompani
Bamboula’s Andy J Forest Quartet
Bayou Bar Peter Harris Quartet
Cafe Negril John Lisi, The Super-Most-FantasticBlues-N-Such Jam
Checkpoint Charlie’s Jamie Lynn Vessels
D.B.A. Treme Brass Band
Dos Jefes Joe Krown
Fritzel’s Jazz Club Fritzel’s All-Star Band ft.
Jamil Sharif
Hot Tin Jason Mayer
Mahogany Jazz Hall Mahogany Hall Swingsters
Rock n Bowl Latin Night with DJ Maynor
Royal Frenchmen Hotel & Bar Trumpet Mafia
Spotted Cat Chris Christy Band, Smoking Time
Jazz Club
The Rabbit Hole Rebirth Brass Band

Tipitina’s Big Chief Juan Pardo & The Golden Comanches, Billy Iuso
Treme Hideaway Juvenile


WEDNESDAY, FEBRUARY 22

30/90 Tajh & The Funky Soles
Apple Barrel The Big Soul Band
Bamboula’s Roule & the Queen
Bombay Club Harry Mayronne & Yvette Voelker
Bayou Bar Peter Harris Trio
Cafe Negril The Budz, Colin Davis
D.B.A. Eric Johanson
DMACS Chris Zonada
Dos Jefes Kris Tokarski
Fillmore Ari Lennox
Fritzel’s Jazz Club Fritzel’s All-Star Band ft.
Kevin Ray Clark
Gasa Gasa Os Mutantes
Irene’s Monty Banks
Kerry Irish Pub Patrick Cooper
MRB Lynn Drury
New Orleans Jazz Museum Young Heroes
Brass Band
Southport Hall Bottomfeeders, Snake Father
Spotted Cat Chris Christy Band, Shotgun Jazz Band
The Dragon’s Den Seux Sexy Sundays
THURSDAY, FEBRUARY 23

Bayou Bar Peter Harris Quartet
Bombay Club Shawan Rice
Cafe Negril Piano Man ‘G’, Sierra Green
D.B.A. Ever More Nest & Loose Cattle, Kelcy Mae
DMACS Paggy Prine, Pizza Man’s Fam Jam
House of Blues Steel Pulse
Irene’s Monty Banks
Joy Theater Hot Mulligan
Le Bon Temps Roulé The Soul Rebels
Spotted Cat Chris Christy Band, Jumbo Shrimp
Jazz Band
The Dragon’s Den Seux Sexy Sundays
FRIDAY, FEBRUARY 24

Bayou Bar Peter Harris Trio
Blue Nile Kermit Ruffins
Cafe Negril Dana Abbott Band, Higher Heights
Chickie Wah Wah Mia Borders
DMACS Gallus Rex
French Market - Dutch Alley (outdoors)
Patrice Fisher & Arpa Quintet
Irene’s Monty Banks
Lakefront Arena Katt Williams
Le Bon Temps Roulé Russell Batiste & Friends
Mid-City Lanes Rock n Bowl Sugar Shaker
NOPSI Hotel Matt Lemmler
New Orleans Jazz Museums Sélène Saint-

Aimé

Orpheum Theater Maggie Rogers
Pour House Saloon Jamie Lynn Vessels
River Shack Gretna Big Al and the Heavyweights
Saenger Theatre John Mellencamp
Santos Bar Bill Callahan
Sheraton New Orleans Hotel Jazz @ the Blue
Dog
Smoothie King Center Alabama
Spotted Cat Chris Johnson Band
The Dragon’s Den Seux Sexy Sundays
The Sazerac House Candlelight: A Tribute to Beyoncé
SATURDAY, FEBRUARY 25
BJ’s Lounge Marina Orchestra & Shark Attack!!
Buffa’s Bar Cole Williams and Papa Mali
Cafe Negril Jason Neville, New Orleans Rug
Cutters
DMACS Aden Paul and Co.
Gasa Gasa Orange Doors
House of Blues Mac Saturn
Le Bon Temps Roulé The Mississippi
Shakedown
Maple Leaf Bar Austin Moonlighters
Mid-City Lanes Rock n Bowl Nashville South
Orpheum Theater
LPO The Music of John Williams
Republic Buku & G REX
Sheraton New Orleans Hotel Jazz @ the Blue Dog
Spotted Cat Panorama Jazz Band, Shake’em Up Jazz Band
The Dragon’s Den Seux Sexy Sundays
The Rabbit Hole Sexbruise?
SUNDAY, FEBRUARY 26
30/90 Single Malt Please Bacchanal Noah Young Trio, Tangiers Combo Bamboula’s Ed Wills Blues 4 Sale






WhereYat.com | February 2023 55 For up-to-date listings visit WhereYat.com New Year... New Luck! Scan to Download Your FREE Lottery App. louisianalottery.com/mardi-gras Play Responsibly Must Be 21 To Purchase. Gambling Problem? Call 877-770-7867. Lottery-WhereYat-Feb23 ad.pdf 1 1/27/23 12:10 PM
MUSIC CALENDAR
JOHN MELLENCAMP AT THE SAENGER THEATRE
Rock and Roll Hall of Famer John Mellencamp is one of the leading acts in the heartland rock genre. Some of his most famous songs include “Jack & Diane”, “Small Town”, and “R.O.C.K. in the U.S.A.”

Friday, February 24, 8 p.m., Tickets start at $125, saengernola.com

Buffa’s Steve Pistorious & His Porch Pals
Bullet’s Sports Bar In Tune Band
Cafe Negril John Lisi & Delta Funk, Vegas Cola
Carrollton Station Tree Stars
D.B.A. Treme Brass Band
DMACS The Love Muscles, Shawn Williams
Dos Jefes Michael Liuzza & Co.
Fritzel’s Jazz Club Fritzel’s All-Star Band ft.
For up-to-date listings visit WhereYat.com

Old Point Bar Romy Kaye & the Mercy Buckets
Spotted Cat Pat Casey & the New Sound


The Dragon’s Den Seux Sexy Sundays
The Howlin Wolf Hot 8 Brass Band
The Maison Higher Heights
MONDAY, FEBRUARY 27
30/90 Piano Man G
Bamboula’s The Melatuan’s
Buffa’s Doyle Cooper Trio
Cafe Negril Cristina Kaminis
Columns Hotel Stanton Moore, James
Singleton, David Torkanowsky
D.B.A. RAM - Haitian Voodoo Rara Music
DMACS Monday Blues Jam
Dos Jefes John Fohl
Fritzel’s Jazz Club Richard Scott & Friends
Gasa Gasa Shape
Mahogany Jazz Hall The Original Tuxedo Jazz Band
Maple Leaf George Porter Jr. Trio
MRB Ben Buchbinder
Palm Court Jazz Cafe Mark Braud
Royal Frenchman Jazz Vipers
Sidney’s Saloon The Amazing Henrietta
Spotted Cat Michael Watson & the Alchemy
St. Roch Tavern Chicken Milk
The Dragon’s Den Seux Sexy Sundays
The Maison Single Malt Please
WEDNESDAY, MARCH 1
Bayou Bar Peter Harris Trio
DMACS Paggy
Prine, Man’s Fam
Jam
House of Blues
Silversun Pickups
Orpheum
Theater Louisiana
Philharmonic Orchestra Presents Haydn’s The Seasons
Santos Bar El Perro
Spotted Cat Chris Christy Band, Jumbo
Shrimp Jazz Band
The Howlin Wolf Apes of the State
FRIDAY, MARCH 3
Cafe Negril Dana Abbott Band, Higher Heights
DMACS Sierra Green
Deutsches Haus Damenchor, Saengerchor
Joy Theater SVDDEN DEATH
Sheraton New Orleans Chris Johnson Band
Tipitina’s Papadosio
SATURDAY, MARCH 4
Cafe Negril New Orleans Rug Cutters, Sierra Green Show
DMACS Pocket Chocolate
House of Blues Gary Brewer, Stephen Marley
Joy Theater Kathleen Madigan
Spotted Cat Soul Brass Band
The Dragon’s Den Seux Sexy Sundays
Mike Fulton
Jazz Playhouse The Wolfe Johns Blues Band
Joy Theater Inner Wave
Le Bon Temps Roulé Dr. Lo Faber
Mahogany Jazz Hall Mahogany Hall
Swingsters ft. Roderick Paulin
Maple Leaf Ricci Krown Trio ft. Wayne
Maureau
Cafe Negril The Budz, Colin Davis
House of Blues Haley Reinhart, Kimbra
Spotted Cat Chris Christy Band, Shotgun Jazz
Band
Toulouse Theatre Adam Melchor
THURSDAY, MARCH 2
Cafe Negril Piano Man ‘G’, Sierra Green
SUNDAY, MARCH 5
Bacchanal Noah Young Quartet, Tangiers
Combo
Cafe Negril John Lisi & Delta Funk,l Vegas
Cola
DMACS R & R Smoking Foundation
Loyola University New Orleans LPO
56 Mardi Gras Manual | Where Y'at Magazine
COURTESY JOHN MELLENCAMP / SAENGER THEATRE


























WhereYat.com | February 2023 57
LAKESIDE2RIVERSIDE
FAMILY GRAS

February 10 & 11
visitjeffersonparish.com
Metairie’s favorite free event, Family Gras, located at the Mardi Gras Plaza on Veterans Boulevard across from the Lakeside Shopping Center, is bringing back its Carnival fun for 2023. This year’s headliners include Rick Springfield, the Jacksons, AJ Croce, the Imagination Movers, and more. The entire family will find plenty of things to enjoy at the event like good food, a kids’ court with national and local artists, games and activities, an art market, lots of great music, the Mardi Gras 5K Race on Saturday at 9:00 a.m., and of course parades. Make sure to stay after the music stops so you can have a good spot for Excalibur, Symphony, and Madhatters parades.
FELIPE'S ENDYMION WATCH PARTY
February 18
felipestaqueria.com
Enjoy the Krewe of Endymion parade and quality Mexican cuisine at the same time at Felipe's Mexican Taqueria’s Endymion Watch Party. The event will take place at Felipe's MidCity location on North Carrollton Avenue. With a purchase of a $100 wristband, you will gain access to a private outdoor patio viewing area for the parade, a complimentary taco bar from 2-6 p.m., two complimentary drink tickets, and access to restrooms and an outdoor satellite bar. The event is limited to 100 entrees, and wristbands will be available for pick up at Felipe's Mid-City’s patio entrance beginning at 1 p.m. on February 18.

ZOOLU 29 & BACCHUS BASH
February 18-20
themetronola.com
There will be plenty of opportunities to party at The Metropolitan during Mardi Gras weekend. First off, make sure to head over on February 18 and 20 for the Zoolu 29 events. Musical headliners include deadmau5 and William Black on Saturday at 9 p.m. and SLANDER and Wax Motif on Monday at 9 p.m. In addition, Bacchus Bash 2023, featuring music by Bag of Donuts, Mannie Fresh, and more, will take place at The Metro on February 19 starting at 12 p.m.

ZULU LUNDI GRAS FESTIVAL

February 20
lundigrasfestival.com
If you’re looking to have a great time right before Mardi Gras day, then make sure to take part in the 29th annual Zulu Lundi Gras Festival. Taking place in Woldenberg Park from 10 a.m. to 6:30 p.m., this free festival is hosted by the 800 members of the Zulu Social Aid & Pleasure Club. There will be lively musical acts for this year’s Lundi Gras Festival. Guests can enjoy lots of classic New Orleans cuisine from a wide array of Louisiana vendors such as Let Us Cater For You, Voleo’s Seafood Restaurant, Sweet Babbie Jay’s, and more.

CLOCKWISE FROM TOP LEFT: COURTESY JEFFERSON CVB / LAZY EYE PHOTOGRAPHY; LUNDI GRAS FESTIVAL; @THE METROPOLITAN/ FACEBOOK; COURTESY BARBARA WILKIE 58 Mardi Gras Manual | Where Y'at Magazine

LAKESIDE2RIVERSIDE
ORPHEUSCAPADE
February 20




kreweoforpheus.com


Celebrate the Krewe of Orpheus’ 30th anniversary at this year’s Orpheuscapade at the Morial Convention Center, which will start at 7 p.m. and is a strictly formal affair. The theme of this year’s event is bringing Orpheus back to its ‘90s roots. Along with monarchs Darren Criss and Joey Fatone, members of ‘90s boy bands 98 Degrees, O-Town, and All-4-One will be present and providing music. There will also be tributes to Tina Turner, Brittany Spears, and Taylor Swift by The Mixed Nuts and Sugar Shaker.


KATT WILLIAMS: 2023 AND ME TOUR
February 24 arena.uno.edu




Stand-up comedian Katt Williams will be bringing his 2023 and Me Tour to the UNO Lakefront Arena. In addition to comedy, Williams has also provided acting roles in projects such as Friday After Next, The Boondocks, Norbit, and Grand Theft Auto IV. The show will begin at 8 p.m. and tickets start at $59 per person. The performance may contain mature adult content, so the show is recommended for ages 18 and over.



THE MUSIC OF JOHN WILLIAMS

lpomusic.com/event
Join the Louisiana Philharmonic Orchestra at the Orpheum Theatre for special performances celebrating the work of legendary film composer John Williams. The Music of John Williams, which will take place at 2:30 p.m. and 7 p.m., will feature not only the LPO but also The Willow School New Orleans Choir and Julian Pellicano as conductor. Audiences will be able to hear live music featured in famous films such as Star Wars, Jurassic Park, , , and more. Tickets start at $25.

60 Mardi Gras Manual | Where Y'at Magazine
. Claiborne Avenue , NOLA 5-6200 ay.com de Avenue) CLOCKWISE FROM TOP LEFT: GUSTAVO ESCANELLE (2); LIVE NATION; WHERE Y'AT STAFF PHOTO ILLUSTRATION (LPO & DISNEY/20TH CENTURY FOX)


Ride The Bull! 522 Bourbon St. bootscootinrodeo
VALENTINE'S DAY [pop] QUIZ
EVERY TIME VAL'S DAY ROLLS AROUND, IT FORCES US TO ASK QUESTIONS WE MIGHT NOT BE READY FOR:

-What's happening here?
VALENTINE'S DAY [pop] QUIZ
Are You in Love?
By Julie Mitchell
-Where is this going?
-Does he know my name?
-Would this legally be considered stalking?
-Should I get a divorce?
Wherever you are in your journey it's very important to know the age old question: Am I in Love? Knowing if you're in love is the first step to a bunch of other important decisions that are all up to you. But how do you know? There's a lot of feelings swirling around in there;
1. Have you ever had a sex dream about them?
2. If you found $1,000 today would what you do with it include them?
3. If you went to karaoke with this person, would you have fun?
4. If they were in a building that was on fire and it felt like you had a shot to save them, would you go in?
5. Would you do drugs with them?
6. Would you let them read some of your journal?
7. Have they ever cheered you up when you weren't feeling good?
8. Do you want to talk to them when you're upset?
9. When they text you, are you excited?
10. Do they make you feel safe?
1-8
Yes's
THIS IS A SITUATIONSHIP
How could you even think you were in love? They don't know you at all and you kind of don't like them. You would not save them from a fire and you are not in love. You have more feelings for beautiful birds than this person. Get out.
9-15 Yes's
HEATING UP OR COOLING DOWN
You have a lot of feelings for this person; it's just not quite love. Either you're in the beginning stages and haven't quite gotten there yet, or it's been many many years and something was lost. Either way, this is a very important person to you, it's just not love. There are still plenty of songs about it though.
16-25 Yes’s
DING DING DING! IT’S LOVE Congratulations, my friend. You are in love. And it seems good. You can look at wedding RSVP’s with ease and talk about hypothetical kids (if that’s your thing)—no problem. It feels like you have a person/partner whom you feel safe with and that values you. Now why can’t you get that with your dad?
how do you really know when it's the big one? Lucky for you, here's a simple quiz of “yes” or “no” questions to sort through all the mess and finally get right down to it: Are You in Love?
• Please circle, then count.
11. Do you have inside jokes?
12. Have you ever daydreamed about them when you were trying to fall asleep?
13. If you committed a crime, would you come to them for help?
14. Would you lend them $50?
15. If you had a weird thing you couldn’t quite see on your back, would you ask them to take a picture or hold a mirror for you?
16. Do you know their drink order?
17. Do you know when their birthday is?
18. If you discovered a magical bean that could grant unlimited wishes, would something beneficial to them make it in the top 10?
19. Have you watched an entire show together?
20. Do they have things at your house (and vice versa)?
21. Have you cried in front of them?
22. Do your friends like them?
23. When you disagree do you still feel respected by them?
24. Have they ever done a dumb thing you like with you that they’re not that into?
25. Would they defend you in a bear attack?
Y / N Y / N Y / N Y / N Y / N Y / N Y / N Y / N Y / N Y / N Y / N Y / N Y / N Y / N Y / N Y / N Y / N Y / N Y / N Y / N Y / N Y / N Y / N Y / N Y / N
= +
ADOBE STOCK
62 Mardi Gras Manual | Where Y'at Magazine


WhereYat.com | February 2023 63
PANCAKES FROM HELL
Why Eating Pancakes on Mardi Gras Can Save Your Soul
By Kathy Bradshaw
Nothing makes Fat Tuesday fatter than stuffing yourself with piles of pancakes

When Fat Tuesday comes around, you’re probably focusing on where to catch the parades or what to put in your go-cup. You’re most likely not thinking about the fact that Carnival season is about to end in a fit of booze and sequins. That the fun will soon be over with nothing to show for it but a bag full of plastic trinkets and a house full of glitter. And you’re surely not thinking about pancakes.
But Mardi Gras Day is also the day before Lent begins. It’s Ash Wednesday Eve. Plus, it’s Pancake Day. So in many places around the world, Mardi Gras is more butter and syrup than it is floats and coconuts.

In religious realms, Fat Tuesday is also known as Shrove Tuesday, so-named for the custom of shriving. This involves confessing one's sins, repenting, and seeking forgiveness. A less-festive equivalent of Carnival, the period leading up to Shrove Tuesday and Lent is therefore otherwise known as Shrovetide. If someone is
wouldn’t keep for 40 days, including butter, eggs, and fat.
So someone had the brilliant idea of using those perishable animal products to make pancakes—because, after all, this is also a day of feasting, a syrupy swan song before the Lenten days of deprivation. And Pancake Day has been a tradition ever since.
Some people even believe that the various pancake ingredients have a religious significance: Eggs symbolize creation or the resurrection, flour represents the staff of life, milk is purity, and salt is wholesomeness. And, they say, the 40 days of Lent are meant to symbolize the length of time that Jesus spent in the desert while fasting and resisting the temptation of Satan (and also, of pancakes).
To celebrate Shrove Tuesday, it’s customary for many churches to hold pancake breakfasts. The church bells chime that morning to call pancake-loving worshippers to come to confession before
bell” is a signal that it’s time for both faith and flapjacks.
Another Shrove Tuesday tradition dates back to approximately 1445 in Olney, Buckinghamshire, in central England. The story goes that a woman was making pancakes at home in her kitchen, in honor of Pancake Day. She was caught with her hands in the batter when the church bells began to toll, announcing the start of the morning service. Knowing that she would be terribly late and prioritizing prayer before pancakes, she bolted out the door, skillet still in hand and apron around her waist, and raced to the church.
Ever since then, many towns throughout England hold pancake races every Mardi Gras Day. To remain true to history, racers in Olney must be female, wear an apron, and flip a pancake in a frying pan as they run through the streets.
A small Kansas town
International Pancake Day, Liberal and Olney go head-to-head, competing on either side of the pond to see which of their runners completes the 415-yard pancake shuffle in the least amount of time.
Many cultures have their own variety of Shrove Tuesday delicacy—there are blinis in Belarus, pączki in Poland, and malasadas in Madeira, for instance. Even though some typical Pancake Day foods around the world are more donut than they are pancake, donuts are technically just a plumper version of a pancake, are they not? Even the pancakes on Fat Tuesday can be fat.
Back in New Orleans, the Mardi Gras go-to meal is almost always Popeyes rather than pancakes, but there’s no reason not to include a little battery goodness on the menu
as well. Who doesn’t love pancakes? Actually, a mere 6% don’t.
Besides, eating pancakes on Pancake Day means that you get to enjoy America’s favorite breakfast and hangover treat, while also being forgiven for all of your unholy trespasses—clean plate, clean slate. Because nothing says repentance like scarfing down a steaming stack of hotcakes. (Put blueberries in them if you’ve been especially sinful.)
Happy Mardi Gras. And may your Fat Tuesday be filled with booze, beads, and Bisquick.

FROM TOP: ADOBE STOCK; KATHY BRADSHAW (2) 64 Mardi Gras Manual | Where Y'at Magazine





WhereYat.com | February 2023 65 Neyow’s Creole Cafe 3332 Bienville St. 504-827-5474 neyows.com Oyster Grill • Full Bar • Patio Seating Your Jazz & Heritage Fest Destination! Neyows.com Book Your Next Function at Neyow’s Palace NeyowsPalace.com XL palace CREOLE CAFE Neyow’s Palace 3317 Bienville St. 504-304-0670 NeyowsPalace.com Neyow’s XL 3336 Bienville St. 504-503-1081 XL.Neyows.com Steak House • Live Jazz Neyow’s XL XL.Neyows.com XL palace CREOLE CAFE
Slice OF LIFE
Slice OF LIFE
Top Spots to Get King Cake by the Slice
Top Spots to Get King Cake by the Slice
By Emily Hingle
King Cakes are a huge business. Even though they've been made for hundreds of years during carnival season, there's been a massive increase in king cake sales in recent years. Perhaps that's due to the amount of king cakes being shipped across the country and more people learning about them. Perhaps social media has made them more popular than ever. There have even been king cake cocktails and burgers. Whatever the cause, king cakes are king during January and February.
Since it has been increasingly difficult to buy a whole cake due to the increase in shipping them, a lot of people have been asking where they can just buy a single slice. The
 following bakeries and cafes are happy to give you a single serving of the best king cakes in New Orleans.
following bakeries and cafes are happy to give you a single serving of the best king cakes in New Orleans.
66 Mardi Gras Manual | Where Y'at Magazine COURTESY DEBBIE DOES DOBERGE
Debbie Does Doberge's Cafe Brulot King Cake by the slice
DEBBIE DOES DOBERGE
1179 Annunciation St. (504) 210-8519, debbiedoesdoberge.com
There's something so heavenly about a melt-in-your-mouth, painstakingly-crafted doberge cake. The delicate confection is made from thin layers of cake alternated with rich layers of pudding to make for an ooeygooey sweet treat. Debbie Does Doberge proudly combined the traditional doberge cake with the seasonal king cake to create something entirely new. And you can pick one up at Bakery Bar or Debbie on the Levee in Kenner (2118 Reverend Richard Wilson Dr.) by the cake or by the slice.
Debbie Does Doberge has two tantalizing options for you. The Cream Cheese King Cake Doberge is seven layers of cinnamon cake holding six layers of cream cheese pudding which are then covered in cream cheese-poured fondant dusted in purple, green, and gold. The Café Brulot King Cake is an homage to the fiery Café Brulot ritual at locals restaurants: cinnamon cake is layered with Café Brulot pudding and then finished with cream cheese icing, coffee buttercream, dehydrated orange slices, and cinnamon cake crunch.
PIETY AND DESIRE CHOCOLATE



2032 Magazine St. (504) 799-1709, facebook.com/ pietydesirechoc
Piety and Desire Chocolate made a name for making delicious little chocolate treats, but they've graduated into being a full-blown café. They proudly pioneered a special king cake called Da Krown that you can get by the slice at the café while you sip some hot coffee.
Da Krown is a creative king cake with earl grey tea and pink peppercorn dark chocolate ganache filling and local satsuma and orange blossom glaze. The top is then sprinkled with cocoa nib, pink peppercorn, bon bon beads, and candied kumquats. Piet y and Desire does not ship their king cakes, so this little treat is a specialty made just for locals or anyone who will travel here just to get it.
COFFEE SCIENCE
410 S Broad St. (504) 814-0878, coffeesciencetogo.com
Coffee Science is a cool coffee shop that has an emphasis on creating community through events, gourmet coffee, and pastries. This season, Coffee Science is selling three very delicious king cakes by the whole cake and by slices meant to be
enjoyed over coffee drinks and conversation.
You have three choices for king cake flavors (and you really can't find these anywhere else):
Venetian Cream, Chocolate Espresso, and completely unique Satsuma. All of the delicious king cakes are coated in a thin layer of glaze and dusted with purple, green, and gold sugar. The nice thing about these king cakes is there's not so much sugar on top that it takes away from the fantastic filling flavor.
WISHING TOWN BAKERY AND CAFÉ
Multiple Locations, wishingtown.com
Wishing Town started off in Metairie (3327 Severn Ave.), but they had to expand to a second location (802 Nashville Ave.) just to accommodate the mass amount of people who come here for lunch specials and to pick up pastries for parties and events. Though Wishing Town's king cakes are in high demand, slices are reserved on Friday, Saturday, and Sunday.
In addition to the traditional king cake, you can have yours filled with coconut, sweet red bean paste, or cinnamon and brown sugar. And for something totally different, The Char Siu King Cake is a brioche dough cake with teriyaki chicken filling and barbecue pork glaze.
BREADS ON OAK
8640 Oak St. (504) 324-8271, breadsonoak.com


Some years ago, Breads on Oak decided to totally go vegan with everything that they make. That's part of the reason that Breads on Oak's king cakes are in such high demand that they can sell out. The other part of the reason is that these king cakes are simply delicious and available by the slice when you go to the shop on Oak Street.
You can get a traditional non-filled king cake, but the flavored ones are just too good to pass up. Bavarian cream, cream cheese, strawberry cream cheese, and even a rich almond cream are your options for an amazing vegan king cake. When you order a whole king cake, an almond is hidden inside instead of a Mardi Gras plastic baby just to make things more natural.
BYWATER BAKERY
3624 Dauphine St. (504) 336-3336, bywaterbakery.com
Bywater Bakery does king cake a little bit differently. Instead of releasing one traditional king

Available now at TheSipThatSlaps.com
cake or even a few filled king cakes, they choose a different unique king cake to make each week. That way, you have to come back once a week to try all of their awesome flavors. They may even have some whole cakes when you arrive, but they are happy to serve it to you by the slice.
If you missed out on the Brownie Bomb and Bouille King Cakes, fret not. They've still got apple, lemon cream, and passionfruit coming out over the course of carnival season. Keep up with Bywater Bakery's social media to see what's currently in store.
THE SWEET LIFE BAKERY
516 Veterans Memorial Blvd. (504) 371-5153, sweetlifenola.com

The Sweet Life Bakery has more options that most other bakeries when it comes to fillings. In fact, they have over a dozen kinds. If you just want to try out some of these flavors, you can stop by the bakery and order a

mini version which is just enough for one, or two if you have the ability to share this deliciousness.
Just some of the available fillings are apple ooey gooey, cherry, vanilla Bavarian cream, cake batter, bananas Foster, chocolate almond, and strawberry ooey gooey. The swirl is a blend of vanilla and chocolate Bavarian cream.
LAUREL STREET BAKERY


2701 S Broad St. (504) 897-0576, laurelstreetbakery.com
You've got to get up pretty early in the morning to catch a slice of king cake at the Laurel Street Bakery. Actually, the bakery is open until 1 p.m., but that's early in the morning to some people. Laurel Street bakery specializes in filled king cakes that are out of this world. It all starts with a dough that is a bit sweeter than traditional brioche, and then it gets wild from there.
The bakery's favorite king cake is Nutella filled, and they swear by it. Other fillings include praline, cream cheese, strawberry cream cheese, almond, and apple. Laurel Street Bakery strictly stops making king cakes on Mardi Gras Day, so you better get here fast if you want to try some.
TARTINE

7217 Perrier St. (504) 866-4860, tartineneworleans.com
Tartine may only serve one style of traditional king cake, but it is so tasty that it can easily sell out. The hidden gem café serves breakfast, lunch, and coffee in the Black Pearl neighborhood, and they serve king cakes during carnival season that have turned into a hot commodity.

This king cake starts with a buttery brioche bread that is filled with cinnamon cream cheese and glazed
with icing and sugar in purple, green, and gold. You'll have to stop by the café to grab a slice or preorder a king cake to understand why this singular king cake has been racking up awards and causing a stir lately.

COCHON BUTCHER
930 Tchoupitoulas St. (504) 588-7675, cochonbutcher.com




Upscale barbecue restaurant and meatery Cochon Butcher is selling slices of only one kind of king cake, and it's a hunka-hunka burnin' cake! You can get one slice of Elvis King Cake to go with your plate of meat. The Elvis King Cake is inspired by the King of Rock 'n' Roll's favorite food: a peanut butter and banana sandwich. This king cake has peanut butter and roasted banana filling and is topped with house-cured bacon.
If you can't help falling in love with the Elvis King Cake, you may be able to get a whole cake to share with your friends and family. Just don't be surprised if the cake has left the building for the day though. It's in high demand. Thank you, thank you very much.
WHERE TO GET KING CAKE
BY
THE SLICE IN NEW ORLEANS
We hope that these bakeries make your list of places to go to get a single slice of king cake. Don't be disappointed if they're all sold out. King cakes are such a big business now that local businesses can hardly keep up with the demand.
68 Mardi Gras Manual | Where Y'at Magazine 7AM – 10PM Validated Parking 401 Poydras • MothersRestaurant.net • (504) 523-9656 PARKWAY FOR POOR BOYS 538 Hagan Avenue | 504.482.3047 Order online at parkwaypoorboys.com Serving New Orleans for over 100 Years
FROM
LEFT: ROBERT WITKOWSKI; COURTESY DEBBIE DOES DOBERGE

IT'S GOOD THE KING
EVERYONE HAS THEIR FAVORITE
The king cake wars are real, and it's hard to choose a favorite with all of the options available. These bakeries tend to be at the top of the list when it comes to talking about who makes the best king cake.
If you'd like to get a super fresh king cake straight from the bakery, these are a baker's dozen of the most popular spots in town.

1. Haydel's Bakery 4037 Jefferson Hwy (800) 442-1342, haydelsbakery.com
Starting on Twelfth Night, there will be a daily line outside of Haydel's Bakery in Old Jefferson. People swear that Haydel's is the ultimate traditional king cake even though they offer a wide variety of flavors. Haydel's begins their king cakes by making a Danish dough and handbraiding it with cinnamon and sugar before baking it. It can be topped with icing, but you can choose to have no icing. In the past, the bakery has infused some of their king cakes with Jameson whiskey and Kahlua.
If you want to have a little more excitement in your king cake, try one of the flavored fillings: praline pecan, cream cheese, strawberry cream cheese, German chocolate, and brownie chocolate chip. Another style is "Da Parish King Cake." This king cake is baked with the sugar on top to make a really crispy crust.
2. Dong Phuong Bakery 14207 Chef Menteur HWY. (504) 882-9878, dpbakery.com
The line for Don Phuong king cakes got so long that the little New Orleans East
Vietnamese bakery had to get their cakes shipped out to be picked up at other locations. The original cinnamon king cake is the most popular item, but Don Phuong also offers cream cheese, pecan, strawberry, almond, and coconut.
Just note that there is a limit of 5 king cakes for online orders and 3 king cakes for walk-in purchases. The bakery opens at 8 a.m., but they are likely to sell out of all king cakes for the day before noon.
3. Manny Randazzo King Cakes

3515 N. Hullen St. (504) 456-1476, randazzokingcake.com





Manny Randazzo and his family had a traditional bakery for decades, but the king cakes were so popular that they decided to devote all their time to making them. The Christmas king cakes are sought after for holiday parties. But the real fun kicks off each January 3rd when they start serving Mardi Gras king cakes. The little Metairie bakery often has a line stretching from the counter down the sidewalk.
Randazzo's has traditional and cream cheese in various sizes, but the Royal King Cake is too good to pass up. It has one section each of strawberry, lemon, and
70 Mardi Gras Manual | Where Y'at Magazine Mon: Closed Tues & Wed Noon-8pm Thurs, Fri & Sat Noon-Midnight | Sun: Noon-10pm 91 FRENCH MARKET PLACE | @jinxnola | @jinx_nola jinxnola.com Big Teasy Burlesque Show 3 P.M. Fat Tuesday
Joe Gambino's King Cake ROBERT WITKOWSKI
TO BE
A Baker's Dozen of King Cake Bakeries
By Emily Hingle
season
year long.
apple filling so that you can get a sampling of excellent flavors all in one. You can really taste the entire history of king cakes with every bite of a Randazzo's king cake.

4. Debbie Does Doberge at Bakery Bar
1179 Annunciation St. (504) 210-8519, debbiedoesdoberge.com


There's something so heavenly about a melt-in-your-mouth, painstakingly-crafted cake. The delicate confection is made from thin layers of cake alternated with rich layers of pudding to make for an ooey-gooey sweet treat. Debbie Does Doberge proudly combined the traditional doberge cake with the seasonal king cake to create something entirely new. And you can pick one up at Bakery Bar by the cake or by the slice. Those not in NOLA can have one shipped nationally via Goldbelly
Debbie Does Doberge has two tantalizing options for you: the cream cheese king cake doberge, which is seven layers of cinnamon cake holding six layers of cream cheese pudding and are then covered in cream cheese-poured fondant dusted in purple, green, and gold, and the Café Brulot king cake, which is an homage to the fiery Café Brulot ritual at locals’ restaurants and is a cinnamon cake that is layered with Café
Brulot pudding and then finished with cream cheese icing, coffee buttercream, dehydrated orange slices, and cinnamon cake crunch.
5. Sucre


3025 Magazine St. (504) 571-5323, shopsucre.com
Sucre is a quaint confectionary located along busy Magazine Street, and they specialize in everything that can be made with sugar and edible glitter. For the carnival season, Sucre releases king cakes that have a slightly more cake-like bread topped with beautiful white icing and glittering colored sugar. It's one of the prettiest king cakes you will ever see, and they're always bakery-fresh.
Sucre is happy to share their king cakes and other confections with the entire country. They offer nationwide shipping so that you can send some Mardi Gras joy to your loved ones.
6. Caluda's Bakery
1536 River Oaks Road West (504) 218-5655, kingcakeshop.com
Caluda's is happy to feed your king cake fix, year-round (even though some say you shouldn't eat king cake outside of carnival season). They can also ship king cakes across the country through their online

WhereYat.com | February 2023 71 COOKING CLASSES PRIVATE EVENTS CATERING Always Hands-On, Always Intimate, Always Fun LOUNGE NOLA Please call or text for info at: (504) 344-3977 Book Online at: www.MGSCNOLA.com GET OVER YOUR HANGOVER! Hangover Remedy Weight Loss Immune Support 717 Toulouse St 519 Wilkinson St @ivloungenola Use Coupon Code IV23 and receive $25 off! Book Now : (504) 302-1056 // ivloungenola.com MIDDLE EAST CUISINE √ A HEALTHY ALTERNATIVE 1500 S. CARROLLTON √ UPTOWN TELEPHONE: 862-6200 / 862-0768 LEBANON’S CAFE DINNERS Shish Kabob (Chicken, Lamb or Beef) √ Lula Kabob (Lamb) √ Hummus w/ Lamb Meat √ Rosemary Lamb Chops Lunch & Dinner Daily (Closed on Tuesdays) Great Selection Of Vegetarian Dishes APPETIZERS Hummus √ Falafel √ Bathenjan Dip (Roasted Eggplant w/ Garlic) √ Vegetarian Grape Leaves
It's finally the time of year when you can indulge in some sweet, cinnamon-y king cake. The traditional New Orleans’ confection is supposed to be eaten only during carnival
from Twelfth Night to Mardi Gras Day, but that still doesn't stop some people from enjoying it all
B o o k
• REHEARSAL DINNERS
• BUSINESS MEETINGS
• SOCIAL OCCASIONS
• INTIMATE RECEPTIONS
For event inquiries contact events@annunciationrestaurant.com

DINE-IN & TAKE OUT THURSD AY– SUND AY 5
101 6 A nnunciation St New Orleans, LA 70130 www.annunciationre staurant.com
ordering system. This Harahan-based bakery is headed by Chef John Caluda and is also known for the crawfish strudel dish found at area festivals. Clearly, he's open to making non-traditional food that people can't get anywhere else.

In addition to the traditional king cake, with or without icing, you can opt for a cream cheese-filled king cake or a delicious praline cream cheese-filled king cake. Have you ever had a strawberry-filled king cake? This might be the year.
7. Joe Gambino's Bakery
4821 Veterans Memorial Blvd. (504) 885-7500, gambinos.com
Joe Gambino's Bakery is the go-to luxury bakery for people wanting a classic doberge cake, especially the half-lemon/half-chocolate kind. But their king cakes also bring customers in when it's the right time of year. Gambino's happily serves king cake year round, however traditionalists will wait for carnival season.
Gambino's has a basic king cake, but you can choose to have no filling, one filling, or two fillings. Praline, strawberry, or chocolate goes great with cream cheese. The fig filling and almond wedding cake filling are showstoppers.
8. Gracious Bakery
Multiple Locations, graciousbakery.com
There are three locations of Gracious Bakery ready to serve you something truly unique: Uptown (4930 Prytania St.), Garden District (2854 St. Charles Ave.), and Mid-City (1000 Norman Francis Pkwy.). The locals love Gracious Bakery's king cakes, or, perhaps galette des rois is more fitting, because these cakes are made in a very old style. A flakey puff pastry is filled with smooth almond cream. This special king cake comes with porcelain fève instead of a plastic baby.
If you want to reserve your king cake in advance (which is advised because they can sell out), you need to have your order in 48 hours before your pick up time.
9. Antoine's Famous Cakes & Pastries
1300 Stumpf Blvd. (504) 368-6222, antoinesfamouscakes.com
While there is a Metairie location, the Gretna location of Antoine's Famous Cakes is always packed during carnival, though the bakery can make their cakes year-round and ship them throughout the U.S., Antoine's didn't just get famous for their king cakes. They're well-known for their queen cakes, which are fit for royalty.
The signature queen cake has five flavors in one cake; each flavor has its own section. You can take a bite of apple, cream cheese, lemon, pineapple, or strawberry filling. Adventurous eaters like to stack the flavors for one very interesting mouthful.
10. Bittersweet Confections
725 Magazine St. (504) 523-2626, bittersweetconfections.com
Bittersweet Confections is more than a bakery. They've got a full breakfast menu, a great lunch menu, and custom cakes for all occasions. When Mardi Gras rolls around, the king cakes are the most popular item. Bittersweet Confections is particularly proud of their chocolate king cake that has
chocolate on the inside and chocolate icing on the outside.
If you don't like regular king cake, you can still enjoy the season with a typical cake that has been beautifully decorated with Mardi Gras colors. It will be so tasty that no one will lodge a complaint about it not being traditional.
11. Hi-Do Bakery
439 Terry Pkwy. (504) 366-6555, facebook.com/hidobakery
New Orleans natives will often say that Hi-Do Bakery's traditional king cake is reminiscent of McKenzie's king cakes. It's simple and sweet, and that's all you really need. Hi-Do Bakery has also been known to make singleserving croissant versions of their popular king cake. Those would be great for an office gift so that you can skip cutting one large cake into slices.
Maybe what makes Hi-Do's king cakes so good is that the founder Mr. Ha Do immigrated to the U.S. and eventually settled in New Orleans. He asked his customers exactly what they wanted, and he made his confections and pastries to their liking.
12. Tartine, 7217 Perrier St. (504) 866-4860, tartineneworleans.com
Tartine may only serve one style of traditional king cake, but it is so tasty that it can easily sell out. The hidden gem café serves breakfast, lunch, and coffee in the Black Pearl neighborhood, and they serve king cakes during carnival season that have turned into a hot commodity.

This king cake starts with a buttery brioche bread that is filled with cinnamon cream cheese and glazed with icing and sugar in purple, green, and gold. You’ll have to stop by the café to grab a slice or pre-order a king cake to understand why this singular king cake has been racking up awards and causing a stir lately.

LAGNIAPPE
Breads on Oak 8640 Oak St. (504) 324-8271, breadsonoak.com
Some years ago, Breads on Oak decided to totally go vegan with everything that they make. That’s part of the reason that Breads on Oak’s king cakes are in such high demand that they can sell out. The other part of the reason is that these king cakes are simply delicious.
You can get a traditional non-filled king cake, but the flavored ones are just too good to pass up. Bavarian cream, cream cheese, strawberry cream cheese, and even a rich almond cream are your options for an amazing vegan king cake. Just to make their king cakes stand out from the rest, Breads on Oak provides an almond to hide instead of a plastic baby.
THE MOST POPULAR KING CAKE BAKERIES IN
If you can't find your favorite king cake at one of these bakeries, then you may not be a big fan of king cake. There's a reason that these places are always packed during Mardi Gras; they love making king cakes, and they put their own spin on this local treat so that they can stand out among the crowd. They are all a part of the amazing history of king cakes and will be for years to come.
72 Mardi Gras Manual | Where Y'at Magazine
NEW
ORLEANS
Y o u r P a r t y N o w !
PM – 10PM Please Call for Reservations (5 04 ) 568 -0245 B o o k Y o u r P a r t y N o w ! • REHEARSAL DINNERS • BUSINESS MEETINGS • SOCIAL OCCASIONS • INTIMATE RECEPTIONS 101 6 A nnunciation St New Orleans, LA 70130 www.annunciationre staurant.com For event inquiries contact events@annunciationrestaurant.com DINE-IN & TAKE OUT THURSD AY– SUND AY 5 PM – 10PM Please Call for Reservations (5 04 ) 568 -0245 Neighborhood Fine Dining in the Heart of the Warehouse District THURSDAY–MONDAY 5PM-10PM B o o k Y o u r P a r t y N o w ! • REHEARSAL DINNERS • BUSINESS MEETINGS • SOCIAL OCCASIONS • INTIMATE RECEPTIONS 101 6 A nnunciation St New Orleans, LA 70130 www.annunciationre staurant.com For event inquiries contact events@annunciationrestaurant.com DINE-IN & TAKE OUT THURSD AY– SUND AY 5 PM – 10PM Please Call for Reservations (5 04 ) 568 -0245 Wednesday thru Monday 5pm-close Reservations@AnnunciationRestaurant.com Book Your Next Event! • REHEARSAL DINNERS • BUSINESS MEETINGS •SOCIAL OCCASIONS •INTIMATE RECEPTIONS 5018 Freret St. • 504-766-9660 @Mr.TequilaNOLA mrtequilanola.com MR. TEQUILA AUTHENTIC MEXICANCUISINE BAR GRILL










WhereYat.com | December 2022 73 INDOOR & OUTDOOR SEATING NOLA,s Foodie Freaks Great Specials Such As Taco Tuesday, Seafood Fridays, and Secret Saturday Specials! 7910 Earhart Blvd. | 504-302-2404 | Open Daily | Brunch Club Sat.–Mon. niceguysnola.com | @Niceguysnola GREAT HAPPY HOUR SPECIALS 2-for-1 Cocktails, $5 Margaritas, and More! CHARGRILLED OYSTERS AUTHENTIC NEW ORLEANS FOOD W/ A TWIST! DJ’S DURING OUR BRUNCH CLUB
$20&UNDERaProofthatpopupscanbetheperfectspotfor romanticValentine'snightout.Pop-upAppeal
 ByKimRanjbar
ByKimRanjbar
Eli's Kitchen 74 Mardi Gras Manual | Where Y'at Magazine ELI'S KITCHEN

WhereYat.com | February 2023 75 nonnoscajuncuisineandpastries.com 1940 Dauphine St. (504) 354-1364 Come and Taste the Love! Yeah, You Right... www.juansflyingburrito.com
Thanks to aggressive marketing campaigns and endless propaganda, February is officially and commercially realized as the month of romance. Not only are we to single out the 14th as a day to lavish expensive attention on our significant others, but the entire month is now celebrated as “Creative Romance Month.”


As anyone in a long-term relationship will tell you, singling out one day (or even



one month) to show romantic appreciation for your partner is not enough. Love doesn't just happen, it's a full-time, yearround endeavor requiring active, engaged participants.

That being said, there's certainly no harm in actively participating in this heart-filled holiday, just as long as you remember to do it again in March (and April and May, etc. ). On that note, instead of doing the same old song and dance—i.e. dinner at a “romantic” restaurant followed by a show—why not go for something infinitely less formal, more affordable, relatively adventurous, and fun? Why not try a new pop-up? Typically held at bars, breweries, indie theaters, and live music venues, many pop-ups are happening where the entertainment factor is already builtin. The atmosphere is casual and the dinnerware typically consists of paper boats and sporks, so there's also no need to dress to impress. These days, there are so many pop-ups, you'll trip over a new one every day of the week. But, there are quite a few floating about with food that's so good, you might just turn into groupies and follow them around the city like Dead Heads, or would you call them Pop-up Peeps? Munching Minions? Hungry Hanger-ons?
Dipping our hands into the vast pool of current New Orleans popups, one that's sure to come out on top is @thecampfryer. Hailing from Newfoundland, James Robbins is a trained chef who's worked in everything “from the



Canadian version of a ‘Louisiana BBQ and Crab Shack,’ to suburban fine dining,” who made his way down here in the midst of shutdowns due to the pandemic. At the time, finding work as a chef was untenable, but with help from the folks at Courtyard and Miel Breweries, Robbins launched a unique style of pop-up all his own. “I think what has made the pop-up successful is having menu items that are unlike anything else on offer in the city,” mused Robbins. “I try to put my own spin on local ingredients available in SE Louisiana, while respecting the traditions and context of the amazing food culture here.”
Follow @thecampfryer and bring your partner to Robbins' next pop-up at Miel Brewery or Wetlands Sake to enjoy dishes like Louisiana lump crab cake with a soft egg and Thai chili jam, boneless chicken wings stuffed with spicy turmeric sausage and drizzled in fish sauce caramel, or the stunning “Hasselback” potatoes draped in a smoked brown butter emulsion and topped with local crab meat. We promise, it's unlike any camp grub you've ever had. While it seems like everyone and their brother's uncle are serving burgers, relative newcomer @degenerateburger is something quite different. After a long

76 Mardi Gras Manual | Where Y'at Magazine Now Hiring! BUY 1, GET 1 25% OFF of equal or lesser value, one coupon per customer per day not valid with other offers, po-boys and gumbo only. Expires February 28, 2023 Download the New Short Stop Po-Boys iPhone App Today for FREE and receive VIP Discounts, Specials, & more! • Oyster • Crawfish • Shrimp • Catfish TRY OUR SEAFOOD PO-BOYS! Call Us For Carnival Trays Now Celebrating Open Monday to Thursday 10:30am to 6:30pm, Fri 10:30am-8pm, Saturday 10:30am to 7:00pm, Closed Sunday • & More shortstoppoboys.com 119 TRANSCONTINENTAL DR. METAIRIE • 885-4572
@thecampfryer
FROM LEFT: @THECAMPFRYER; @DEGENERATEBURGER
@degenerateburger




career as a Navy air traffic controller, North Carolina-native Scott Hedge stepped away from the control room to grill burgers. “I’ve always had a passion for cooking, and during Covid, I obsessed over burgers,” says Hedge. “I would cook burgers several times a week for my friends.” In July 2022, Irish Channel bar Pete's Out in the Cold offered Hedge his first pop-up opportunity and it's been gangbusters ever since. A self-proclaimed “burger corrupter,” the patties you get @degenerateburger feature everything from poached pears and chevre to his Oktoberfest special with dark lager beer cheese on a pretzel bun. @degenerateburger has appeared all over town in spots including Carrollton Station, Miel Brewery, Henry's Uptown Bar, and Parleaux Beer Lab, but, more often than not, you'll find Hedge grilling his heart out at Pete's.
Cross over the Mississippi and discover Mexican street food from @eli_skitchen Though she was born in California, Elizabeth Martinez grew up in Mexico watching her mother, grandmother, and aunts cook and sell food from home. Later on, her family moved back to the states and opened a restaurant here in Louisiana. Though their restaurant has since closed, Martinez couldn't escape the pull of the industry and like many other recent start-up stories, launched her own business during the pandemic. “I cooked birria and posted it on my Facebook [page and] everyone kept telling me they wanted some and that it looked so good,” says Martinez. “I built up the courage and said, ‘Okay. I'll sell plates.’ I never thought I was going to get such a huge response.”
For the past year, @eli_skitchen has been offering the fan favorite quesabirria tacos, burritos, noodles, and more at Stained Glass Wine House in Gretna

but just recently began offering her birria bounty every Tuesday, Saturday, and Sunday at Beside “the” Point on General Meyer Avenue.


Get Your Mom & Dim Sum
For the ultimate in public displays of affection, you can feed your loved one bite-sized morsels @geturdimsum (a.k.a. Get Your Mom & Dim Sum), a pop-up led by Andrew Lu. Born and raised in Lafayette, this skilled young chef (whose father was also a chef) graduated from the Louisiana Culinary Institute in Baton Rouge and honed his skills in local restaurants such as Gianna and Cavan. His idea for the pop-up was born, like so many others, during the height of the pandemic. “I found myself out of a job,” says Lu. “Things were hard, but I knew that I still had so much that I wanted this town to experience with my food.” With help from veteran chef Cristina Quackenbush of Milkfish, Lu was able to get his pop-up off the ground. Now @geturdimsom can be found everywhere from Skeeta Hawk Brewing and NOLA Nite Market to Stained Glass Winehouse and Mid-City Art Studios serving dishes including crispy crab rangoons with sweet chili sauce, kung pao noodles, and strawberry cheesecake dumplings with red velvet cake crumbles and white chocolate glaze.
Lastly, though, we're still just scraping the surface. Grab a blanket and enjoy a picnic-style feast of sandwiches @hungrybard.nola. Charlottesville, Virginia-natives Penn Camp and Jeremy Potter have been playing it somewhat under-the-radar (socially-media-







speaking) with their sandwich-driven installments at Broadside Theater and Zony Mash Beer Project. The @ hungrybard.nola pop-up launched with the intention of “filling a hole” they saw in the local 'wich market. Put your ears to the ground and you'll be rewarded with between-the-bread offerings including a beef bourguignon-like beauty with chive mash and a wine reduction on rye or their “cowboy pastrami” with pimento cheese and candied jalapenos. Aren't adventures deliciously romantic?

78 Mardi Gras Manual | Where Y'at Magazine BOTTOMLESS BRUNCH SAT. & SUN. 10AM-3PM 329 DECATUR STREET • 504-373-4852 Cajun Cookin Makes You Good Lookin’! evangelineneworleans.com @evangelineneworleans evangline.nola
FROM TOP: @ELI_SKITCHEN; @HUNGRYBARD.NOLA
@hungrybard.nola.
















WhereYat.com | February 2023 79 Call [504] 891-0144 to Advertise! DON’T MISS THE SPRING RESTAURANT GUIDE / ST. PATRICK’S DAY ISSUE DEADLINE: FEB 23 | STREET DATE: MARCH 3 Our Private Room - Fine Dining & Social Distancing At Its Best! Gather Safely With Family & Friends in Private! Delicious Food from Briquette, Full Bar, Amazing Wines, & More! Inquiries at Briquette-Nola.com 302-7496 701 S. Peters, Warehouse District Call (504) 766-6519 or Order Online! inside GITA PITA GITA PITA
RESTAURANT GUIDE
AMERICAN
Crescent City Steakhouse has been taking steaks to a whole new level for four generations. The restaurant is known for sizzling its steaks in butter. They also have hearty options such as lobster tails and gratin. 1001 N. Broad St., | (504) 821-3271 | crescentcitysteaks.com
Daisy Duke’s is a great place for some of the best Southern cooking in NOLA. They serve lunch and dinner options such as po-boys and gumbo. Don’t forget to order Daisy Duke’s award-winning Cajun Bloody Mary. Multiple Locations | daisydukesrestaurant.com
Gattuso’s serves New Orleans’ and bar favorites in Gretna’s historic district. Their bar is always fully stocked. They also have happy hour all day Tuesdays and from 2 to 6 p.m. on Wednesday through Saturday. 435 Huey P Long Ave., Gretna | (504) 368-1114 | gattusos.net
Houmas House hosts five different restaurants within its grounds. Each restaurant offers fresh farm-to-table Louisiana cuisine. Be sure to try The Carriage House’s Louisiana ribs and the rabbit gumbo at Latil’s. 40136 LA-942, Darrow | (225) 473-9380 | houmashouse. com
JB’s Fuel Dock serves up mouth-watering pizzas and rotating specials to satisfy guests’ appetites. The restaurant overlooks Lake Pontchartrain. Guests can meet new friends over cocktails and JB’s supreme pizza. 126 S. Roadway St. | (504) 510-2260 | jbsfueldock.com
Jimmy J’s is “N’awlins’s funkiest lil’ café”. They boast unique breakfasts, scrumptious desserts, and amazing signature cocktails such as the Bloody Mary and Irish coffee. Be sure to order the Black Angus burger. 115 Chartres St. | (504) 309-9360 | jimmyjscafe.com
Legacy Kitchen’s Steak + Chop offers top Southern comfort food. Delicious sandwiches and prime steaks are available. The restaurant also has a strong emphasis on cocktails as well as a quality wine service. 91 Westbank Expy. #5, Gretna | (504) 513-2606 | legacykitchen.com
Luke is a Creole-influenced brasserie in the CBD. A vibrant ambiance surrounds a raw bar providing fresh seafood and oysters from the Gulf of Mexico. Try the jumbo Louisiana shrimp or the pork schnitzel. 333 St. Charles Ave. | (504) 378-2840 | lukeneworleans.com
Lakeview Harbor has been serving Typhoon cocktails for the past 30 years. The juicy cheeseburger is the perfect thing to enjoy while you’re there. The restaurant also has a long list of beer to try. 8550 Pontchartrain Blvd. | (504) 486-4887 | lakeviewharbor.us
Manning’s Sports Bar & Grill is the perfect setting to spend time with friends and family. Manning’s features over 30 flat-screen TVs, leather recliners, and classic pub food. Try their traditional wings and nachos 519 Fulton St. | (504) 593-8118 | caesars.com
New Orleans Vampire Café is perfect for those who go bump in the night. Feast on exquisite dishes such as grilled portobello with tofu. Get replenished with the café’s Blood Bag Cocktails. 801 Royal St. | (504) 581-0801 | nolavampirecafe.com
NOLA Steak is located in Boomtown Casino and is the perfect place to take a break from the blackjack tables. Go for the 18-ounce cowboy steak. NOLA Steak is open Thursday through Saturday for dinner. 4132 Peters Rd., Harvey | (504) 366-7711 | boomtownneworleans.com
Spudly’s Super Spuds has served locals “meals in baked potatoes” for over 40 years. Treat yourself to the “Shrimply Put Potato”. Spudly’s serves their potatoes, burgers, salads, and po-boys in a modest, no-fuss setting. 2609 Harvard Ave. | (504) 455-3250 | spudlys.com
Steakhouse at Harrah’s is a place where guests can enjoy delicious steakhouse classics. Try the ribeye steak, which is delivered with a loaded baked potato. Order classic cocktails like a Sazerac or a French 75. 228 Poydras St. | (504) 533-6111 | caesars.com

Ugly Dog Saloon offers some of the best BBQ around. Here’s the spot to satisfy your cravings while watching your favorite sports team. Try the Lafitte Pig and enjoy Ugly Dog’s outdoor seating. 401 Andrew Higgins Blvd. | (504) 569-8459 | theuglydogsaloon.com
Voodoo Chicken and Daiquiris is an all-new experience serving up the best fried chicken and fresh fruit daiquiris in town. Be sure to try some of their famous wings and signature cocktails all in a fun, fresh atmosphere. And yes, the kitchen is open late. 629 Canal St. 504-345-2222 voodoochickenanddaiquirisnola.com
Crescent City Steakhouse
ASIAN
Asia is one of the many quality restaurants located in Boomtown Casino. The restaurant serves Chinese and Vietnamese dishes like General Tso’s chicken. Fried rice and tofu vegetables are also available. 4132 Peters Rd., Harvey | (504) 366-7711 | boomtownneworleans.com
Mikimoto has been NOLA’s destination for authentic Japanese fare for the past 20 years. Guests can expect delicious sushi in a cozy environment. Try the Geaux Saints Maki Roll or the Sex in the City Roll. 3301 S. Carrollton Ave. | (504) 488-1881 | mikimotosushi.com
Thai'd Up offers modern Thai street food right in the Fairgrounds area. Try the restaurant’s homemade beef jerky or butter Thai shrimp. Stay refreshed and order the restaurant’s Thai tea or jasmine tea. 1839 Gentilly Blvd. | (504) 354-8202 | thaidupla.com
BARS WITH GREAT FOOD
Alto Rooftop Bar, located on top of the Ace Hotel, is the best hangout spot for swimming, drinking, and eating. Try the lettuce wrap with Gulf shrimp. Be sure to come during happy hour
for $8 specialty drinks. 600 Carondelet St. | (504) 900-1180 | acehotel.com
Buffa's Bar & Restaurant is known as “the best place you’ve never been”. The restaurant has been serving the Marigny neighborhood since 1939. Stop by for a Reuben and visit during Buffa’s traditional jazz brunches. 1001 Esplanade Ave. | (504) 949-0038 | buffasbar.com
Down the Hatch Bar and Grill offers pub fare in a casual, lively bar setting in the Garden District. Try the alligator po-boy or fried catfish platter. You can even order Mediterranean plates. 1921 Sophie Wright Pl. | (504) 5220909 | downthehatchnola.com
JINX Bar & Grill offers good food right in the heart of the Quarter. Enjoy tasty sandwiches and burgers like the Big Kahuna. The bar also has tasty shareable plates like the JINX Wings and Foghorn Fingers. 91 French Market Pl. | (504) 510-2797 | jinxnola.com
Le Bon Temps Roule is an iconic neighborhood bar in Uptown. This bar is known for being open 24/7 and for offering live music. It has one of the best Bloody Marys in the city and the pimiento bacon burger can’t be beat. 4801 Magazine St. | (504)-897-3448 | lbtrnola.com
Peacock Room is a beautiful, upscale bar in the Kimpton Hotel Fontenot. The bar serves luxury spirits and creatively-made cocktails. The Peacock Burger with truffle fries and a secret sauce is not to be missed. 501 Tchoupitoulas St. | (504) 324-3073 | peacockroomnola. com
Stumpy’s Hatchet House provides a safe environment for guests to throw hatchets. It’s the perfect place to blow off some steam. Stumpy’s offers a snack area where guests can enjoy hot dogs and popcorn. 1200 Poydras St. | (504) 577-2937 | stumpyshh.com/ neworleansla
The Country Club New Orleans features a beautiful interior with a cabana lounge and a pool. It serves food influenced by ItalianFrench and Creole-Southern heritages. Come for weekend brunch from 10 a.m. to 3 p.m. 634 Louisa St. | (504) 945-0742 | thecountryclubneworleans.com
The Garage is a great place to enjoy live music and tasty food. The club regularly has open mic nights, so get out there and sing your heart out. Be sure to try The Garage’s fried okra and other Southern classics. 810 Conti St. | thegaragemusicclub.com
The Jimani offers upwards of 100 beers, pub cuisine, and several TVs. Customers can start off with an appetizer such as fried pickle spears. Classic entrées include Mama’s chicken club and the Hangover Burger. 141 Chartres St. | (504) 524-0493 | thejimani.com
The Marsh Room Patio Bar and Grill has a nice collection of entrees and cocktails. The restaurant also regularly hosts karaoke nights The Marsh Room serves specialty 75 cent wings on Sundays. 4740 Rye St., Metairie | (504) 571-5733 | facebook.com/marshroom
Tracey's Original Irish Channel Bar is one of the city’s best sports bars. Classic dishes like burgers and red beans and rice are available. It’s a great place to catch up with some friends over some oysters, po-boys, and beer. 2604 Magazine St. | (504) 897-5413 | traceysnola.com
CAFE
Carmo is a tropical-based restaurant with flavors from the Caribbean to Southeast Asia.
80 Mardi Gras Manual | Where Y'at Magazine
ROBERT WITKOWSKI




WhereYat.com | February 2023 81 Scan to see all airport shopping & dining options It’s the season of indulgence so eat, splurge and enjoy! HAPPY MARDI GRAS
RESTAURANT GUIDE

Try their Burmese tea leaf salad and tiradito smothered in aji Amarillo pepper sauce. Their menu also has healthy options for vegans and vegetarians. 527 Julia St. | (504) 875-4132 | cafecarmo.com
Meril is Chef Emeril’s fourth restaurant in New Orleans and is located in the Warehouse district. The casual, cool vibe of the restaurant is the perfect setting for delicious craft cocktails or wine served with some of Lagasse’s favorite dishes like fettuccine Nero and wood fired flatbreads. 424 Girod St. | (504) 526-3745 | emerilsrestaurants.com
The Vintage is perfect for dates because of its Instagram-worthy décor. There are so many unique sandwiches and cocktails to choose from. Make sure to stop by for different flavored beignets. 3121 Magazine St. | (504) 3247144 | thevintagenola.com
Willa Jean is a retro-chic café that has Southern fixings and mouth watering desserts. Regulars love the infamous WJ Milk and Cookies. Willa Jean was voted as the No. 2 Best Bakery by Southern Living Magazine. 611 O'Keefe Ave. | (504) 509-7334 | willajean.com

FRENCH
Bar Marilou is nestled next to the Maison de la Luz hotel. The drink menu includes signature cocktails such as the Blind Serpent and the Tokyo Record. Try Bar Marilou’s frogs’ legs and crispy potatoes with caviar. 544 Carondelet St. | (504) 814-7711 | barmarilou.com
Cafe Degas serves traditional French cuisine with slight Creole influences. The restaurant is the longest running French bistro in New

Orleans. Café Degas provides ample outdoor seating, as well as the option for curbside pickup. 3127 Esplanade Ave. | (504) 945-5635 | cafedegas.com
Café Normandie is located in the Higgins Hotel, which is the official hotel of the National WWII Museum. The menu has options such as eggs benedict and signature flat breads. Bring a friend and split a charcuterie board. 1000 Magazine St. | (504) 5281941 | higginshotelnola. com
ITALIAN
Domenica, inside the Roosevelt Hotel, combines local ingredients with sacred cooking techniques to create delicious dishes. Choose from a variety of uniquely crafted pasta. Try their pork ragu lasagna. 123 Baronne St. | (504) 648-6020 | domenicarestaurant. com
Josephine Estelle, located inside the Ace Hotel, is an elaborately decorated osteria. The menu blends Italian cuisine with flavors from the American South. You’ll be sure to love Josephine Estelle’s rigatoni. 600 Carondelet St. | (504) 930-3070 | josephineestelle.com
Mosca’s has served some of Louisiana’s best Creole-Italian food for over 60 years. Sample the famous Shrimp Mosca. From friendly staff to family-style portions, Mosca’s will make you feel right at home. 4137 US-90 West, Westwego | (504) 436-8950 | moscasrestaurant.com
Felipe's
has fantastic Sicilian and Italian-Creole cuisine, as well as excellent customer service. The restaurant is a legacy of Frank Catalanotto’s family. Try their fresh mussels
ovens that were custom-made and shipped from Italy. Their tangy, cheesy Calabrese pizza is one of the best on the menu, so be sure to try it. Multiple Locations | pizzadomenica.com

offers authentic Italian cuisine in historic Algiers Point. Tavolino is known for their delicious, thin crust pizzas. Their drinks menu features signature cocktails, wines, and a selection of different beers. 141 Delaronde St., Algiers | (504) 605-3365 | tavolinonola.com
Venezia has been serving Mid-City since 1957 and specializes in pizzas cooked in a stone oven. Grab a seat at the bar for a super cocktail before ordering. Make sure to get the chicken parmigiana. 134 N. Carrollton Ave. | (504) 4887991 | venezianeworleans.net
MEXICAN
Empanola has the best empanadas in the city. They make unique empanadas such as Beef Argentina, Chorizo Mexicana, and Gumbo. They even have vegetarian options like Mushroom and Cheese, as well as Spinach and Artichoke. Multiple empanolaempanadas.com
Felipe’s Mexican Taqueria, located at three different locations, offers casual, authentic Mexican food made from scratch. They’re



ENRIQUE MONZON
WWW.THEVINTAGENOLA.COM
3121 MAGAZINE STREET | (504) 324-7144


WhereYat.com | February 2023 83
Your Favorite Mardi Gras Snack! Your Favorite Mardi Gras Snack!
RESTAURANT GUIDE


has been serving tasty Mexican fare for 26 years. A fun, happening place, Juan’s serves burritos, quesadillas,





art brewpub. Visitors should try their freshlyshucked oysters, steak, and hot wings. Ask for balcony seating to get breathtaking views of the
evolved from an Italian grocery store

Come during the week and try their daily specials
Order the pecan crusted redfish with green beans
with a focus on seafood and steak. Try the whole fried red snapper, served with lemon and a butter
day, so you can enjoy eggs and grits at any time.
84 Mardi Gras Manual | Where Y'at Magazine
4 4 4 S t . C h a r l e s A v e . I n t e r C o n t i n e n t a l H O T E L
s e e M E N U s
@trenasse



WhereYat.com | February 2023 85
Orleans Grapevine has been specializing in fine dining since the 19th century. The brick walls and 200-year-old cast iron pillars make this place perfect for a date. Their hand grenade martini comes in a souvenir martini glass. 720 Orleans St. | (504) 523-1930 | orleansgrapevine.com
Parkway Bakery & Tavern first opened as a bakery in 1911. The menu features a variety of po-boys like shrimp and roast beef. Watch the Saints game at Parkway’s large outdoor patio, which has two 65-inch TVs. 538 Hagan Ave. | (504) 482-3047 | parkwaypoorboys.com
Short Stop Poboys has been serving Metairie since 1966. They have a huge selection of traditional po-boys. Pair your po-boy with stuffed artichokes or Short Stop’s house-made gumbo. 119 Transcontinental Dr., Metairie | (504) 885-4572 | shortstoppoboysno.com


Trenasse , located in the Intercontinental Hotel, pays homage to Louisiana fishers and hunters. The smoky braised short ribs, as well as the oysters, are strong recommendations. Make sure to try the Out of the Blue martini. 444 St. Charles Ave. | (504) 680-7000 | trenasse.com
Willie Mae’s Scotch House makes the best fried chicken in all of the United States. The owner, Ms. Willie Mae Seaton, even won the coveted James Beard award. Try the crispy fried chicken with butter beans and mac ‘n’ cheese. Multiple Locations | williemaesnola.com

SEAFOOD

Bon Temps Boulets serves some of the tastiest seafood, smoked BBQ, and po-boys in town.




Thhe Galley















Located in Metairie, Bon Temps takes pride in their boiled crawfish. Other menu items not to be missed are their po-boys, especially their 24-hour brisket, fried green tomato and shrimp, and gulf oyster. 4701 Airline Dr. | (504) 885-5003 | bontempsboulets. com


Briquette prides itself on its contemporary dining space and open kitchen. The restaurant has an 18-inch display filled with fresh seafood. Try the Snapper Pontchartrain with lump crabmeat, hollandaise, and heirloom tomatoes. 701 S. Peters St. | (504) 302-7496 | briquette-nola. com
Felix’s Restaurant and Oyster Bar’s tasty oysters have gained a cult following around the world. Their Lakeshore Drive location is best for watching beautiful sunsets. Be sure to enjoy other classic dishes like gumbo and jambalaya. Multiple Locations | felixs. com
Legacy Kitchen’s Tacklebox features refined American fare cuisine. Try their famous chargrilled oysters, which are soaked in a garlic parmesan butter. Challenge your taste buds with the Bloody Mary Oyster Shooters. 817 Common St. | (504) 827-1651 | legacykitchen.com

Seaworthy is located in a Creole cottage that was built in 1832. It was opened by the Ace Hotel with help from Grand Banks. Seaworthy is available for private dining for groups of 16-20 people. 630 Carondelet St. | (504) 930-3071 | seaworthynola.com
Tito’s Ceviche and Pisco is devoted to serving high-quality Peruvian cuisine. Their menu has a variety of ceviches and piscos. Stop by for happy hour every weekday from 3-6 p.m. or Sunday brunch from 10:30 a.m. until 3 p.m. Multiple Locations | titoscevichepisco.com
86 Mardi Gras Manual | Where Y'at Magazine
RESTAURANT GUIDE 1001 N Broad St, New Orleans, LA 70119 crescentcitysteaks.com (504) 821-3271 89 Celebrating YEARS OF BUSINESS
HOT & FRESH • BOILED JUMBO SHRIMP & CRABS • JUMBO SNOWCRABS • 12 ENTRÉE SALADS • 8 OZ FILETS W/ SIDES • FRIED CHICKEN DINNERS • SEAFOOD DINNERS: –FRIED, BOILED, GRILLED –HOMEMADE ROAST –BEEF PO-BOYS –DAILY LUNCH SPECIALS –TOP SHELF COCKTAILS –CRAWFISH ETOUFEE OUR CRAWFISH ARE HUGE! GRAB A CALUDA’S KING CAKE WHILE YOU ARE HERE! NOW OPEN TUESDAYS! Tuesday - Friday, 11AM to 9 PM Saturday, 12 PM to 9 PM FAMILY OWNED & OPERATED 2535 METAIRIE RD. 504-832-0955 WHERE Y'AT STAFF Lebanon's






WhereYat.com | February 2023 87 Daisy Dukes 121 Chartres St. French Quarter Daisy Mae’s 902 Poydras St. Warehouse District Daisy Dukes Express 123 Carondelet St. CBD Daisy Dukes Cafe 308 St. Charles Ave. CBD Daisy Dukes 1200 W. Approach Mandeville Daisy Dukes 2244 Veterans Blvd. Kenner Come visit any of our 7 locations: AWARD BLOODYWINNING MARYS BLOODY Daisy Dukes 5209 W. Napoleon Ave. Metairie daisydukesrestaurant.com Serving •Breakfast •Lunch •Dinner!
Bar Guide
Alto (Ace Hotel)
600 Carondelet St. 504-900-1180

Babylon Sports Bar
2917 Harvard Ave., Suite A 504-324-9961

Bar Marilou
544 Carondelet St. 504-814-7711
Boot Scootin’ Rodeo
522 Bourbon St. (504) 552-22510 4132

Club 38 4132 Peters Rd. 504-366-7711
Evangeline
329 Decatur St. 504-373-4852
Fillmore New Orleans 6 Canal St. 504-881-1555
House of Blues 225 Decatur St. 504-310-4999
Jinx Bar and Grill 91 French Market Pl., 504-510-2797
Lots A Luck Tavern 203 Homedale St. 504-483-0978
Martine’s Lounge
2347 Metairie Rd. 504-831-8637
Pal’s Lounge
949 N. Rendon St. 504-488-7257
Rosie’s on the Roof 1000 Magazine St. 504-528-1941
Stained Glass Winehouse
201 Huey P Long Ave. 504-812-0930
Stumpy’s Hatchet House
1200 Poydras St., Suite C 504-577-2937

The Garage 810 Conti St.
The Marsh Room Patio Bar & Grill 4740 Rye St. 504-571-5733


The Metropolitan 310 Andrew Higgins Blvd. 504-568-1702
The Rabbit Hole 1228 Oretha Castle Haley Blvd. 504-354-9709
The Royal Frenchmen Remedy Bar 700 Frenchmen St. 504-619-9660
Tracey’s Original Irish Channel Bar 2604 Magazine St. 504-897-5413
Treme Hideaway 1234 Claiborne Ave. 504-301-4441
Tropical Isle Multiple Locations 504-523-1927
Ugly Dog Saloon & BBQ 401 Andrew Higgins Blvd. 504-569-8459
Located on top of the Ace Hotel, Alto is a chill spot to hang out with your friends. You can cool down with some of the bar’s signature cocktails like Calypso and Turkish Royale.
Babylon is a great place to watch football and listen to live music in Metairie. The bar also provides a homey atmosphere with reasonable prices on all of their drinks.

Bar Marilou has a sophisticated French-style atmosphere in a very beautiful location alongside the Maison de la Luz hotel. The bar offers plenty of wine, beer, and craft cocktails.
If you’re in the mood for country, Boot Scootin’ Rodeo is your place. This country bar plays good old music and serves cold beer and cocktails. Mechanical bull included.
Located inside Boomtown Casino & Hotel in Harvey, Club 38 is the perfect VIP experience. Available through Boomtown’s mychoice® loyalty program, guests can enjoy complimentary food and drinks after signing up.
Evangeline provides some of the best Cajun food that can be found in the French Quarter. Enjoy local craft beers and other drinks the restaurant offers like the strawberry blonde or the rum punch.
The Fillmore is a beautiful, state-of-the-art 22,000 square-foot entertainment space above Harrah’s Casino. While there for a night of live music, make sure to grab a cocktail in BG’s Lounge.
The House of Blues offers one of the best nightlife experiences in all of NOLA. Choose from a long list of beers, wines, and more and jam out to one of the venue’s many live music events.
Located right next to the French Market, JINX has an extensive beer list and top-notch cocktails such as the Decatur Mule, El Guapo, and Blue Milk. It offers hookahs with different flavors to choose from.
Lots A Luck Tavern is one of the best places in New Orleans to play bar games. Watch the next big football game while enjoying some cold beer or some of the bar’s other refreshments.
Cold beer and other specialty drinks including frozen Irish coffee, cherry limeade, and frozen sangria await at Martine’s Lounge. Pop-ups are frequently are on-site to offer food.
Open from 3 p.m. to 3 a.m., Pal’s Lounge is one of New Orleans’ perfect late-night spots. Some of Pal’s most popular, and affordable, drinks include the gingerita, the watermelon mojito, and the bacon Bloody Mary.
Located atop of the Higgins Hotel, Rosie’s surrounds guests with World War II-era Americana. Cold beer and delicious small plates like fries loaded with brisket and bacon cheese curds are available.
Stained Glass is Gretna’s premiere self-serve wine bar. This upscale, unpretentious bar offers over 300 wine bottles and 24 self-serve wine taps, as well as spirits, draft beer, and cocktails.
Stumpy’s Hatchet House gives patrons the perfect opportunity to test their hatchet-throwing skills. Light snacks and refreshing drinks from Stumpy’s fully-stocked bar are available for a quick pick-me-up.
Enjoy all sorts of entertainment like live music and open mic nights at The Garage. In addition to a fully stocked bar, the venue offers tasty NOLA favorites such as gumbo and spicy beef yaka mein.
The Marsh Room is one of the best establishments to hang out at in Metairie. While sipping on your favorite drink, grab some bites such as cheese curds, steak, and the bar’s “Marsh burger.”
The Metropolitan is one of New Orleans’ premiere nightclubs. While partying with your friends, make sure to visit the multiple different bars located all around the large, two-story club.
The Rabbit Hole is a truly eclectic club that always provides a great night of fun. Enjoy the venue’s outdoor and indoor stages for live music, as well as The Rabbit Hole’s downstairs bar.
The Royal Frenchmen Hotel is a cozy spot to stay to be close to the Frenchmen Street action. It also features a great bar in the lobby with a fantastic Happy Hour and live music on the weekends.
Beer lovers will be happy when they see Tracey’s six draught taps and over 100 bottles of different brands to choose from. The bar also serves delicious oysters, poboys, and more.

Treme Hideaway is one of New Orleans’ best kept secrets. Tucked away in the historic Treme neighborhood, locals can flock to this night club for R&B music, DJ sounds, and hot food.
Tropical is a Bourbon Street staple that is beloved by both tourists and locals. The bar is best known for being the birthplace of the “hand grenade,” aka New Orleans’ most powerful drink.
Complete with beer, 15 TVs, and an outdoor patio, Ugly Dog Saloon is the perfect spot to watch the Saints game. Enjoy delicious, smoky BBQ classics such as Buffalo fried ribs and smoked pulled pork.
88 Mardi Gras Manual | Where Y'at Magazine
Dancing Billards Drink Specials Food Live Music
METRY’S HOME OF LIVE MUSIC & THE “MARSH BURGER!” FOLLOW US ON 4740 RYE ST., METAIRIE Serving authentic tacos, pozole and menudo! Now serving beer! 208 N. Carrollton Ave // 504-484-6959 9AM-9PM Tues.-Sun. @Taqueriaguerrero17 Taqueria Guererro T Taqueria Guererro JOIN US THIS CARNIVAL SEASON FIRST & ONLY CCBNO.COM �� ��








WhereYat.com | February 2023 89 Joe’s Septic & Fencing Contractors 985-632-5592 • JoesSeptic.com •Festivals •Weddings &FamilyReunions •MardiGrasEvents •OilFieldPigRoasts •OtherEvents OFFERING •Tents&TemporaryFencing •PortableToiletes •A/CRestroomTrailers •HandWashStations •EyeWashunits NEED HELP THROWING YOUR FESTIVAL? CALL US FOR ALL YOUR FENCING, TOILETS, HANDWASHING STATIONS, A/C TRAILERS & MORE! Joe’s Ready When You Are! 1921 SOPHIE WRIGHT PL, NEW ORLEANS, LA 70123 1921 SOPHIE WRIGHT PL, NEW ORLEANS, LA 70123 ( ) Down The Hatch BAR & GRILL 1921 SOPHIE WRIGHT PL., NEW ORLEANS, LA 70123 504-522-0909 OPEN DAILY 11AM – 2AM a INDOOR & DOG FRIENDLY PATIO SEATING BEST WINGS IN TOWN! Come party with us before and after the parade! ⚜ ⚜ ✨ ✨ ✨ ✨ ☂ ☂
FILM REFLECTIONS
For Black History Month
By Jeff Boudreaux
As we celebrate Black History Month, it is important to surround ourselves in films that celebrate the African American experience. The following films undoubtedly take us from the bad times (namely the racism that dominated our society for so long), through the Civil Rights legislation that made it possible for black films to be produced on a large scale, to an outright explosion of black entertainment in the 1970s.
Most importantly, these films beckon the viewer to reflect upon the struggles of African Americans, even if it forces us outside of our comfort zones. Here are six classic film suggestions; each one is selected for inclusion in the Library of Congress’ National Film Registry due to their “historical, cultural, and aesthetic significance.” All of these films entertain and inform, while providing a starting point for a continued appreciation into the joys of black cinema.
Cabin in the Sky (1943) – From MGM and producer Arthur Freed, comes this lavish, all-black musical based upon the 1940 Broadway hit. Directed by the great Vincente Minnelli, legendary singers Ethel Waters and Lena Horne represent the good and bad women in the life of backsliding Little Joe (Eddie “Rochester” Anderson). When Joe is killed in a barroom fight and given an extra six months to live, will he choose the heavenly road alongside his sweet wife Petunia and guardian angel The General (Kenneth Spencer), or follow Lucifer Jr. (Rex Ingram) and femme fatale Georgia Brown into Hades? Co-

starring Louis Armstrong as a trumpet-playing emissary of hell and featuring a rousing number by Duke Ellington, the film also features the standards “Happiness is a Thing Called Joe” and “Taking a Chance on Love.” You can watch this delightful musical on streaming services.
Guess Who’s Coming to Dinner (1967) – This is what important films are made of—a black doctor (Sidney Poitier) is engaged to the white daughter (Katharine Houghton) of a well-to-do, supposedly “liberal” couple—played by screen legends Spencer Tracy and Katharine Hepburn. Drama ensues between both sets of prospective in-laws. To call this film groundbreaking is selling it short: It was released merely 6 months after Loving v. Virginia legalized miscegenation and is certainly the greatest film ever made concerning interracial marriage. It was also the ninth and final screen pairing of Tracy and Hepburn and was completed only 17 days before Tracy’s death. Nominated for 10 Oscars, and winner of two (Hepburn and screenwriter William Rose), the basic premise was copied time and again in films – most recently as part of a horror setting in Jordan Peele’s Get Out

90 Mardi Gras Manual | Where Y'at Magazine FROM TOP: SONY PICTURES; WARNER BROS.
A Raisin in the Sun (1961) – Sidney Poitier stars in this adaptation of Lorraine Hansberry’s stage play about a black family anticipating the arrival of a
Guess Who's Coming to Dinner?
Cabin in the Sky

$10,000 life insurance check. Walter Lee Younger (Poitier) believes he needs the cash for an entrepreneurial, get-richquick scheme involving liquor stores, whereas his mother Lena (Claudia McNeil) and wife Ruth (Ruby Dee) would rather use the money to remove their family from the projects. Meanwhile, Lena’s daughter Beneatha (Diana Sands) dreams of attending medical school and moving to Nigeria with exchange student Joseph Asagai (Ivan Dixon). Unbelievably, this groundbreaking film was snubbed by the Oscars, instead picking up awards from nearly every other film festival and academy. It co-stars Louis Gossett Jr. and is directed by Daniel Petrie, who took home the “Gary Cooper Award for Human Values” from Cannes. Available to watch on most streaming services.

The Learning Tree (1969) – Solidifying its place in the annals of motion picture history, this was the first Hollywood film written and directed by an African American—pre-eminent photojournalist-turned-filmmaker Gordon Parks (Shaft). Newt Winger (Kyle Johnson) is a boy growing up in 1920s Kansas, who learns all about life, death, love, and hate, as only a black person could in the Jim Crow South. A poignant coming-of-age drama, it’s surprising that this film hasn’t received more accolades than it has over the years. Based on Parks’ semi-autobiographical 1963 novel of the same name, The Learning Tree was one of the first 25 films to be selected for inclusion in the National Film Registry. Available to watch on most streaming services or as part of a magnificent 2K restoration from the Criterion Collection.
Sounder (1972) – Nominated for four Academy Awards including Best Picture, Actress and Actor, Cicely Tyson and Paul Winfield star in this heart-warming tale of destitute sharecroppers in Louisiana. When his father is sent to an undisclosed prison camp for stealing meat, David Lee (Kevin Hooks) must divide his time between helping his mother tend crops and searching for his daddy’s location. For those unfamiliar with the Newberry Medal-winning novel that the film is based on, the title refers to the family dog, who does play a significant part, but this movie rather wisely focuses instead on the story’s human aspect. Filmed entirely on-location in St. Helena and East Feliciana Parishes. Taj Mahal (who plays Ike) composed the film’s Grammy-nominated soundtrack, and it was the first film produced by famous toy manufacturer Mattel. Available to watch on YouTube.




Cooley High (1975) – Two teenage boys chase girls, hustle, and get in all kinds of scrapes while approaching an important midterm exam at the titular, Chicago vocational school. Preach (Glynn Turman) is an aspiring screenwriter and Cochise (Lawrence Hilton-Jacobs) already has a basketball scholarship to Grambling, yet their future may be in jeopardy following runins with peers who don’t have such high aspirations. Co-starring original “Not Ready for Prime Time Player” Garrett Morris as Mr. Mason, history teacher, and mentor to our protagonists. Oh! And for fans of Motown, this film contains one of the best soundtracks you will ever hear. Directed by Michael Schultz (Car Wash, Greased Lightning), this hilarious comedy-drama is available to watch on YouTube

92 Mardi Gras Manual | Where Y'at Magazine
2101 N. Rampart St. 504-944-7068 1100 N. Peters, Farmers Market Stall #9 lap@lorettaspralines.com lorettaspralines.com @lorettaspralines The egacy Continues! CLOCKWISE FROM FROM TOP LEFT: SONY PICTURES; LEGACY DISTRIBUTION; MGM; WARNER BROS. A Raisin in the Sun
Cooley High The Learning Tree
Sounder







FILM REVIEWS
By David Vicari & Fritz Esker
Living 80 for Brady
The British drama Living is a remake of Ikiru, a 1952 Japanese picture by the great Akira Kurosawa, which, itself, is inspired by the 1886 Russian novella The Death of Ivan Ilyich by Leo Tolstoy. Living is a very respectable retelling with a brilliant, low-key performance by [Academy Award nominee for Best Actor] Bill Nighy at its center.
The setting for Living is London of 1953, and Nighy plays Rodney Williams, a bureaucrat in the county Public Works department. He's a rather cold man who wakes up in the morning, goes to work, then heads home, then to sleep, and repeat. One day at the doctor's office, however, Mr. Williams gets the devastating news that he has a terminal illness with maybe nine months to live.
At first, Williams thinks he should go out with a bang and live a life of fun, like boozing it up or playing games at the carnival. As it turns out, this isn't fulfilling to him. He wants to do something
meaningful with his life, so he decides to dedicate the time he has left to getting a playground erected in the lower class section of town.
Throughout the film, we see Williams through the eyes of different characters like the new hire, Peter Wakeling (Alex Sharp), or the charming young lady of the office, Margaret Harris (Aimee Lou Wood). The relationship between Williams and Ms. Harris is quite lovely. Williams takes her to lunch and out for drinks, and the old man's adult children get the wrong idea. Sure, Williams clearly sees an attractive young woman in Harris, but he just enjoys her company because of her zest for life. Living is directed by Oliver Hermanus (Beauty, Shirley Adams) with an adapted screenplay [also nominated for an Academy Award] by Kazuo Ishiguro (The Remains of the Day, Never Let Me Go), and together they have crafted a thoughtful film that is never cloying or artificially “feel good.” It earns its emotions because nothing here even feels false.

The first 20 minutes feel a little stuffy, but it's supposed to be that way, because Williams' life is monotonous. Please, stay with the film, as the rewards are many. —David Vicari
There haven’t been a lot of straight-up comedies to be released in theaters since the pandemic. Some articles have postulated that people are unwilling to see simple comedies in theaters in a streaming era (but I dispute this since 2019’s Good Boys and 2022’s Ticket to Paradise were hits at the box office). So it’s nice to see that trend appears to be changing with releases like 80 for Brady. The film is sitcom-esque in both good ways and bad, but it benefits greatly from the work of its four leads (Sally Field, Lily Tomlin, Rita Moreno, and Jane Fonda).
The four senior ladies are friends who became New England Patriots fans during Tom Brady’s first season. Watching the games served as a distraction and an inspiration for Louella (Tomlin) as she battled cancer and went through chemo treatments.

Cut to early 2017, and the Patriots are in another Super Bowl with Brady.
Louella talks her friends into traveling from Boston to Houston for the big game.

Of course, complications big and small arise. Some jokes are funny; others elicit eye-rolls. But the movie’s strength is reminding viewers how funny the leads are. Hollywood is notoriously stingy when it comes to leading roles for older women, so it’s nice to see these gifted actresses back in the spotlight again. Even when the film is at its silliest, you still root for them. Saints fans will also enjoy seeing game footage of the Patriots’ miraculous comeback victory from down 28-3 late in the 3rd quarter vs. the Falcons. Viewers unfamiliar with the work of the movie’s leads should check out All of Me (Tomlin), 9 to 5 (Tomlin, Fonda), and Absence of Malice (Field). —Fritz Esker

94 Mardi Gras Manual | Where Y'at Magazine
Call [504] 891-0144 to Advertise! DON’T MISS THE SPRING RESTAURANT GUIDE / ST. PATRICK’S DAY ISSUE DEADLINE: FEB 23 | STREET DATE: MARCH 3 You Can’t See Mardi Gras Without… Stopping at Mardi Gras Zone! FROM LEFT: SONY PICTURES CLASSICS; PARAMOUNT PICTURES










WhereYat.com | February 2023 95 Earn $10 in Free Slot Play for every 100 Tier Credits within 24 hours of becoming a Caesars Rewards® member. Redeem once at any Caesars Rewards Kiosk at Harrah’s New Orleans. O er valid for new Caesars Rewards members only. EARN UP TO $100 IN FREE SLOT PLAY Non-transferable and non-negotiable. Additional restrictions may apply. Not valid with any other offer. Valid at Harrah’s New Orleans only. This offer not intended for excluded patrons. All other trademarks used herein are owned by Caesars License Company, LLC and its affiliated companies. All other trademarks not owned by Caesars that appear herein are the property of their respective owners. Must be 21 or older to gamble. Know When To Stop Before You Start.® Gambling Problem? Call 1-877-770-STOP. ©2022, Caesars Entertainment.
TALES
FROM THE QUARTER


 By Debbie Lindsey
By Debbie Lindsey
Forever Home, Forever Dreams, Forever Expenses
The American dream of home ownership can be perilous and an adventure to say the least.
There’s a mysterious pop sound. Then, twenty minutes later, another. Then a flash/spark of light burst forth from the electric wall heater. Oh! and all the electric outlets on one side of the house don’t work. They did; now they don’t.
Welcome to Day Two of home ownership. And why am I only prescribed ten itty bitty strength valiums a year? Sure the electric stuff will be replaced, repaired, and made safe, but then there’s the roof, foundation, sewer lines, not to mention the rain gutters. Ah! but it is all ours—not counting the bank and natural disaster’s first dibs on it.
I will never be able to enjoy hurricane season again. Instead of panic-shopping for beer, wine, stockpiles of toilet paper, and pet food, I will be buying tarps, fire extinguishers (actually always had this item), and regretting not having storm windows. I can picture myself flung across the roof to protect the shingles. No more hurricane parties. I will just be staying alert all night reviewing my flood insurance policy by candle light—nix the candles, they’re a hazard.
Winter freezes will be another thing, too. I never ever enjoyed approaching cold fronts, but now I will really hate them. As a tenant, we always did our utmost to protect the pipes, the outside washer, and water heater. Last big freeze, I went outside during the night with a blow dryer to warm exposed pipes and ran the dryer to warm the washer. But now all the cats, our dog, Philipe, and I will have to sleep under the house to warm and cuddle the pipes. And you think I am kidding.
I have never owned a house, never uttered the word escrow. Now terms like mortgage, title, lender, estimate, discloser, promissory, and security instrument are nails on the chalkboard to my ears. And the word “documents” fills my heart with dread and my brain with ADHA confusion and overload. Just writing about this has the chronic stress-triggered pinched nerve in my back vying for attention. I have writer’s cramps from signing my name in full legal and legible form.
But not all this house hunting and house buying has been painful—much of it has been educational and eye opening. And while it has always filled me with terror to see termite damage on any building anywhere, I now go weak in the knees when I pass a sagging roof, cracked rain gutters pouring water over unprotected window sills, or vinyl siding camouflaging rotting exteriors with
lead-based chipping paint. I even look under random houses and shudder at the foundations. But as I said the house hunting has been informative and I walk past buildings now with a curious and keen eye. I notice slate roofs, eaves (closed, boxed and open), gutters, different types of porches and stoops and does the rental side of the double include a handrail (required by insurance). I already had a bit of knowledge of the various styles of architecture found in New Orleans, but now I look to see what kind of attic ventilators adorn the roofs. And my observation does not stop with the houses themselves: Are the trees planted too close to sewer lines? Of course I look to see if the AC compressor is mounted on the roof or ground level. Oh the slippery slope of house gazing—speaking of which aren’t those tile steps a liability when it rains?
Clearly I am not totally on board with this home ownership thing. Most folks congratulate us with enthusiasm and seem a bit saddened when I respond with my POW look. I feel trapped and frightened beyond belief. Husband sees a “Forever Home,” and I see foreclosure documents. He wants me to take a leap of faith as I teeter at the edge of a cliff. But a leap was made and the hurdle is high and there are and will be plenty of scraped shins as we climb into home ownership.
Oh! Did I tell you? We are now landlords. As you may know most of our New Orleans houses are doubles (duplexes). Used to be this set-up would provide the homeowner with income via the tenants’ rent—not so much the case anymore. If you want to not be a part of the problem that renters in this town now face, you can only raise the rent just enough to break-even with the ever rising expenses of ownership.
There is no denying the house has good bones despite a bit of osteoporosis. She is 130 years old but a tough old bird. Yes, she is a lady. I view most houses as of the female persuasion and skyscraper type architecture as male what with the obvious phallic look. She has retained so much of her original charm and despite my best efforts to wish away this purchase it seems this house wants us—like it was simply meant to be (or it’s akin to a staph infection that won’t go away). Regardless, she is ours now and like a feral cat, we simply must nurture her back to health. She will from now on be named Miss Money Pit. This name, this title, is given with a degree of affection and is most befitting. I will do my best to tend to her and respect the history and craftsmanship of this house. I will make it our home.
96 Mardi Gras Manual | Where Y'at Magazine TAMAR TAYLOR / TAMART




WhereYat.com | December 2022 97 WE SELL LEGAL THC Please visit rashop.us PIPES • CBD • VAPES • DETOX • KRATOM Winner Best Smoke Shop 2016 - 2022 BATON ROUGE 3275 HIGHLAND RD. (225) 338-0081 5201 NICHOLSON DR. (225) 763-9091 LAFAYETTE 1905 NW EVANGELINE TRWY (337) 232-0000 HATTIESBURG, MS 2706 HARDY ST. (601) 261-6961 COVINGTON 2900 N. HWY 190 (985) 893-2748 MANDEVILLE 2198 FLORIDA ST. (985) 674-1644 HAMMOND 1000 N. OAK ST. (985) 902-8380 SLIDELL 758 1-10 SERVICE RD. (985) 649-7262 FRENCH QUARTER 733 TOULOUSE ST. (504) 875-3067 1209 DECATUR ST. (504) 528-2351 NEW ORLEANS 8128 OAK ST. (504) 864-8288 3118 MAGAZINE ST. (504) 894-7934 METAIRIE 3828 VETERANS STE. B (504) 889-8436 NOW OPEN! New Locations 739 Bourbon St. New Orleans LA 70116 1519 Hwy 22, Suite 8 Madisonville LA 70447 NOW HIRING Good Times Rolling
PO-BOY VIEWS
By Phil LaMancusa
Love and Death or M*A*S*H
Humor me. Think about yourself and your life as a pair of lovers (even if it’s just you and yourself) holding hands and walking through Armageddon, seeing each other in each other's eyes, and picking your way through the rubble of destroyed buildings and broken bodies, heedless of cries for help and succor, as you make your way to sanctuary—a place to make gentle love. Life is like that if you’re lucky enough to see the turmoil happening around you from an unscathed vantage point. Happy Valentine’s Day. You deserve it.
Death and destruction around us is viewed either subjectively or objectively, and we can watch and read the news of hell on earth and either be touched deeply by it or be impatient for the next feel good story. We can be callous because of our need for self protection. No one needs to be empathetic and live. That much pain would be unbearable.
Oh, we’re not apathetic, by any means. It’s called psychic numbing. Why We Love Dogs, Eat Pigs and Wear Cows (Melanie Joy, Ph.D.) cites that our system works this way. We love animals (insert people), and we don’t want to see them suffer. We have three choices (insert when we witness or participate in misery and/or cruelty). We can change our values to match our behavior, change our behavior to match our values, or we can change our perceptions of our behavior so that we appear to match our values. The third option is the way our system works when we can love on our pets but allow ourselves to rationalize forty million turkeys being slaughtered for our holiday dinners.
I’ve been watching a lot of M*A*S*H lately; actually I’ve just finished all of the eleven seasons. I’ve taken away two things from M*A*S*H besides the terrific acting. One is that Hawkeye, Radar, Klinger, and Hot Lips (and the rest of the cast) are some funny, funny people. The second is that the underscoring their antics from virtually the first episode is they view the war as senseless, but their view cannot stop the bodies that continually wind up coming in, necessitating them to repair them (when they can), and, if they’re well enough, send these unfortunates back to fight in this senseless war. All through the mud and the blood and the beer, there’s the senseless war.








That’s what we have here.
People are dying senselessly all around us, and we, as individuals, can do nothing to stop this from occurring and continuing; paying attention to this only brings me a feeling of impotence, yet I cannot turn away. It’s like watching a train wreck in slow motion.
Here’s a quick quiz. I’ll give you the situation, and you fill out the location:
Starvation in ___? War in_____?
Hurricane____? Earthquake___?


Tornados___?
Environmental disasters ___?


Mass shootings____ ?

Homelessness ___? Poverty ___?
Prejudice ___? Greed? ___?
That last one’s a ringer and the answer to that one is “everywhere.” You might consider that some of the conditions of those other quiz questions can be due to greed.
It works due to your greedy politicians being given campaign money by a greedy polluter, manufacturer, real estate developer, and/or power-hungry wealthy donor. The politicos use that money to further their ambitions for power (a type of greed) while getting legislations passed that perpetuate the businesses and ambitions of the donors and/or turn a blind eye on their inhumanity, or, simply put, money talks.
Who takes it in the shorts? The answer to that is really simple—the whole world. What can we do about it? Nothing. It’s too overwhelming. It’s frigging crushing to even think about it. How do we, as a society, create enough Mackenzie Scotts to counteract all of the you-know-who’s?
Well, Hawkeye Pierce and B.J. Hunnicut would know the answer: be kind, sarcastic, a pain in the ass, and complain, point out discrepancies in the system, and refuse to participate in its inequities, as well as vote, get involved, do something useful for no reward or recognition, and pay attention. Be better.
Sure, on M*A*S*H most everybody’s getting laid (or trying to), playing practical jokes on each other, getting drunk, eating lousy food, and living in lousy conditions, but, in spite of all that, when the wounded come in and the broken bodies get to the operating room, there’s no monkeying around. It’s all business. That’s another lesson to learn—put people’s welfare and wellness ahead of our selfish convenience. Which would you rather see: a pig drinking beer or a hog getting its throat cut (or a dog, a horse, or a person)?
Valentine’s for me is not only a celebration of love, but a time for pre-spring evaluation of my habits and behavior. Say what you want about January 1st, my new year starts with the Vernal Equinox (that’s my story and I’m stickin’ with it). So I think this year I’ll adopt the Hippocratic tradition and think of myself as a person who will conduct their life by “[f]irst, do no harm,” and second, refusing to support anyone who does harm.
That’s a tall order and a noble thought. It's gonna take a lot of will power and strength. Therefore, I will go to another source of courage, fortitude, wisdom, and instruction. I am now committing myself to watching all the episodes of Golden Girls
After that maybe Frank’s Place, and then maybe Will and Grace and so on.
A joyous Valentine’s to you. May you, by day, enjoy nature and, by night, take life lessons from Sophia Petrillo
98 Mardi Gras Manual | Where Y'at Magazine •ZULU 29TH ANNUAL•
Monday, February 20 | Woldenberg Park 10 am – 6:30 pm | No Cover Charge! Zulu Ensemble, Kermit Ruffins, Sun Pie Barnes & The Louisiana Sunspots, Big Frank & Lil Frank, The Brass-A-Holics, Tereasa B and N Style, & many, many more. Plus All Your Favorite Zulu Characters Including King & Queen 2023 VIP Seating Available As Well As Food From The City’s Top Restaurants VIP Tickets are available at eventbrite.com Visit KreweofZulu.com For More Info
Celebrating King Zulu-Elect – Nicholls “Nick” Spears
































WhereYat.com | February 2023 99
BROOKE LAIZER SEFENECH HENOK TAMICA LEE
WHERE Y'BEEN
INTERGALACTIC KREWE OF CHEWBACCHUS PARADE









JOAN OF ARC PARADE



100 Mardi Gras Manual | Where Y'at Magazine
OUT & ABOUT WITH
FAN EXPO
PUSSYFOOTERS BLUSH BALL
ALL PHOTOS: GUSTAVO ESCANELLE








102 Mardi Gras Manual | Where Y'at Magazine WHERE Y'BEEN OUT & ABOUT WITH BIG NIGHT NEW ORLEANS 610 STOMPERS BALL FEBRUARY 24 – MARCH 18 Friday & Saturday at 8 pm THERE’S A STORY BEHIND EVERY DREAM 767 Robert Blvd // Slidell, LA 70458 985-649-3727 // cuttingedgetheater.com Tickets Starting at $32 Text 985-285-6666 for Discounted Tickets Reservations strongly advised DREAMGIRLS Cutting Edge Theater THE MUSICAL ALL PHOTOS: GUSTAVO ESCANELLE














nolahalloweenstore . com 107 Chartres Street • 504-302-2095 NIKKI’S HALLOWEEN STORE We Also Carry Kryolan, Mehron, European Body Art, Fever, Alchemy, Scarecrow Fangs, Dental Distortions, Tinsley Transfers, Wigs, Tutus, Blood, Liquid Latex, Hair Coloring, Eyelashes, Prosthetics, Make Up: High Definition, Waterproof, UV Reactive, Glow in the Dark



















































 ROMNEY CARUSO
By Emily Hingle
ROMNEY CARUSO
By Emily Hingle





















































































































































































































































 By Frances Deese
By Frances Deese















































































































































































































































































































 following bakeries and cafes are happy to give you a single serving of the best king cakes in New Orleans.
following bakeries and cafes are happy to give you a single serving of the best king cakes in New Orleans.











































 ByKimRanjbar
ByKimRanjbar


























































































































































































































































 By Debbie Lindsey
By Debbie Lindsey






































































